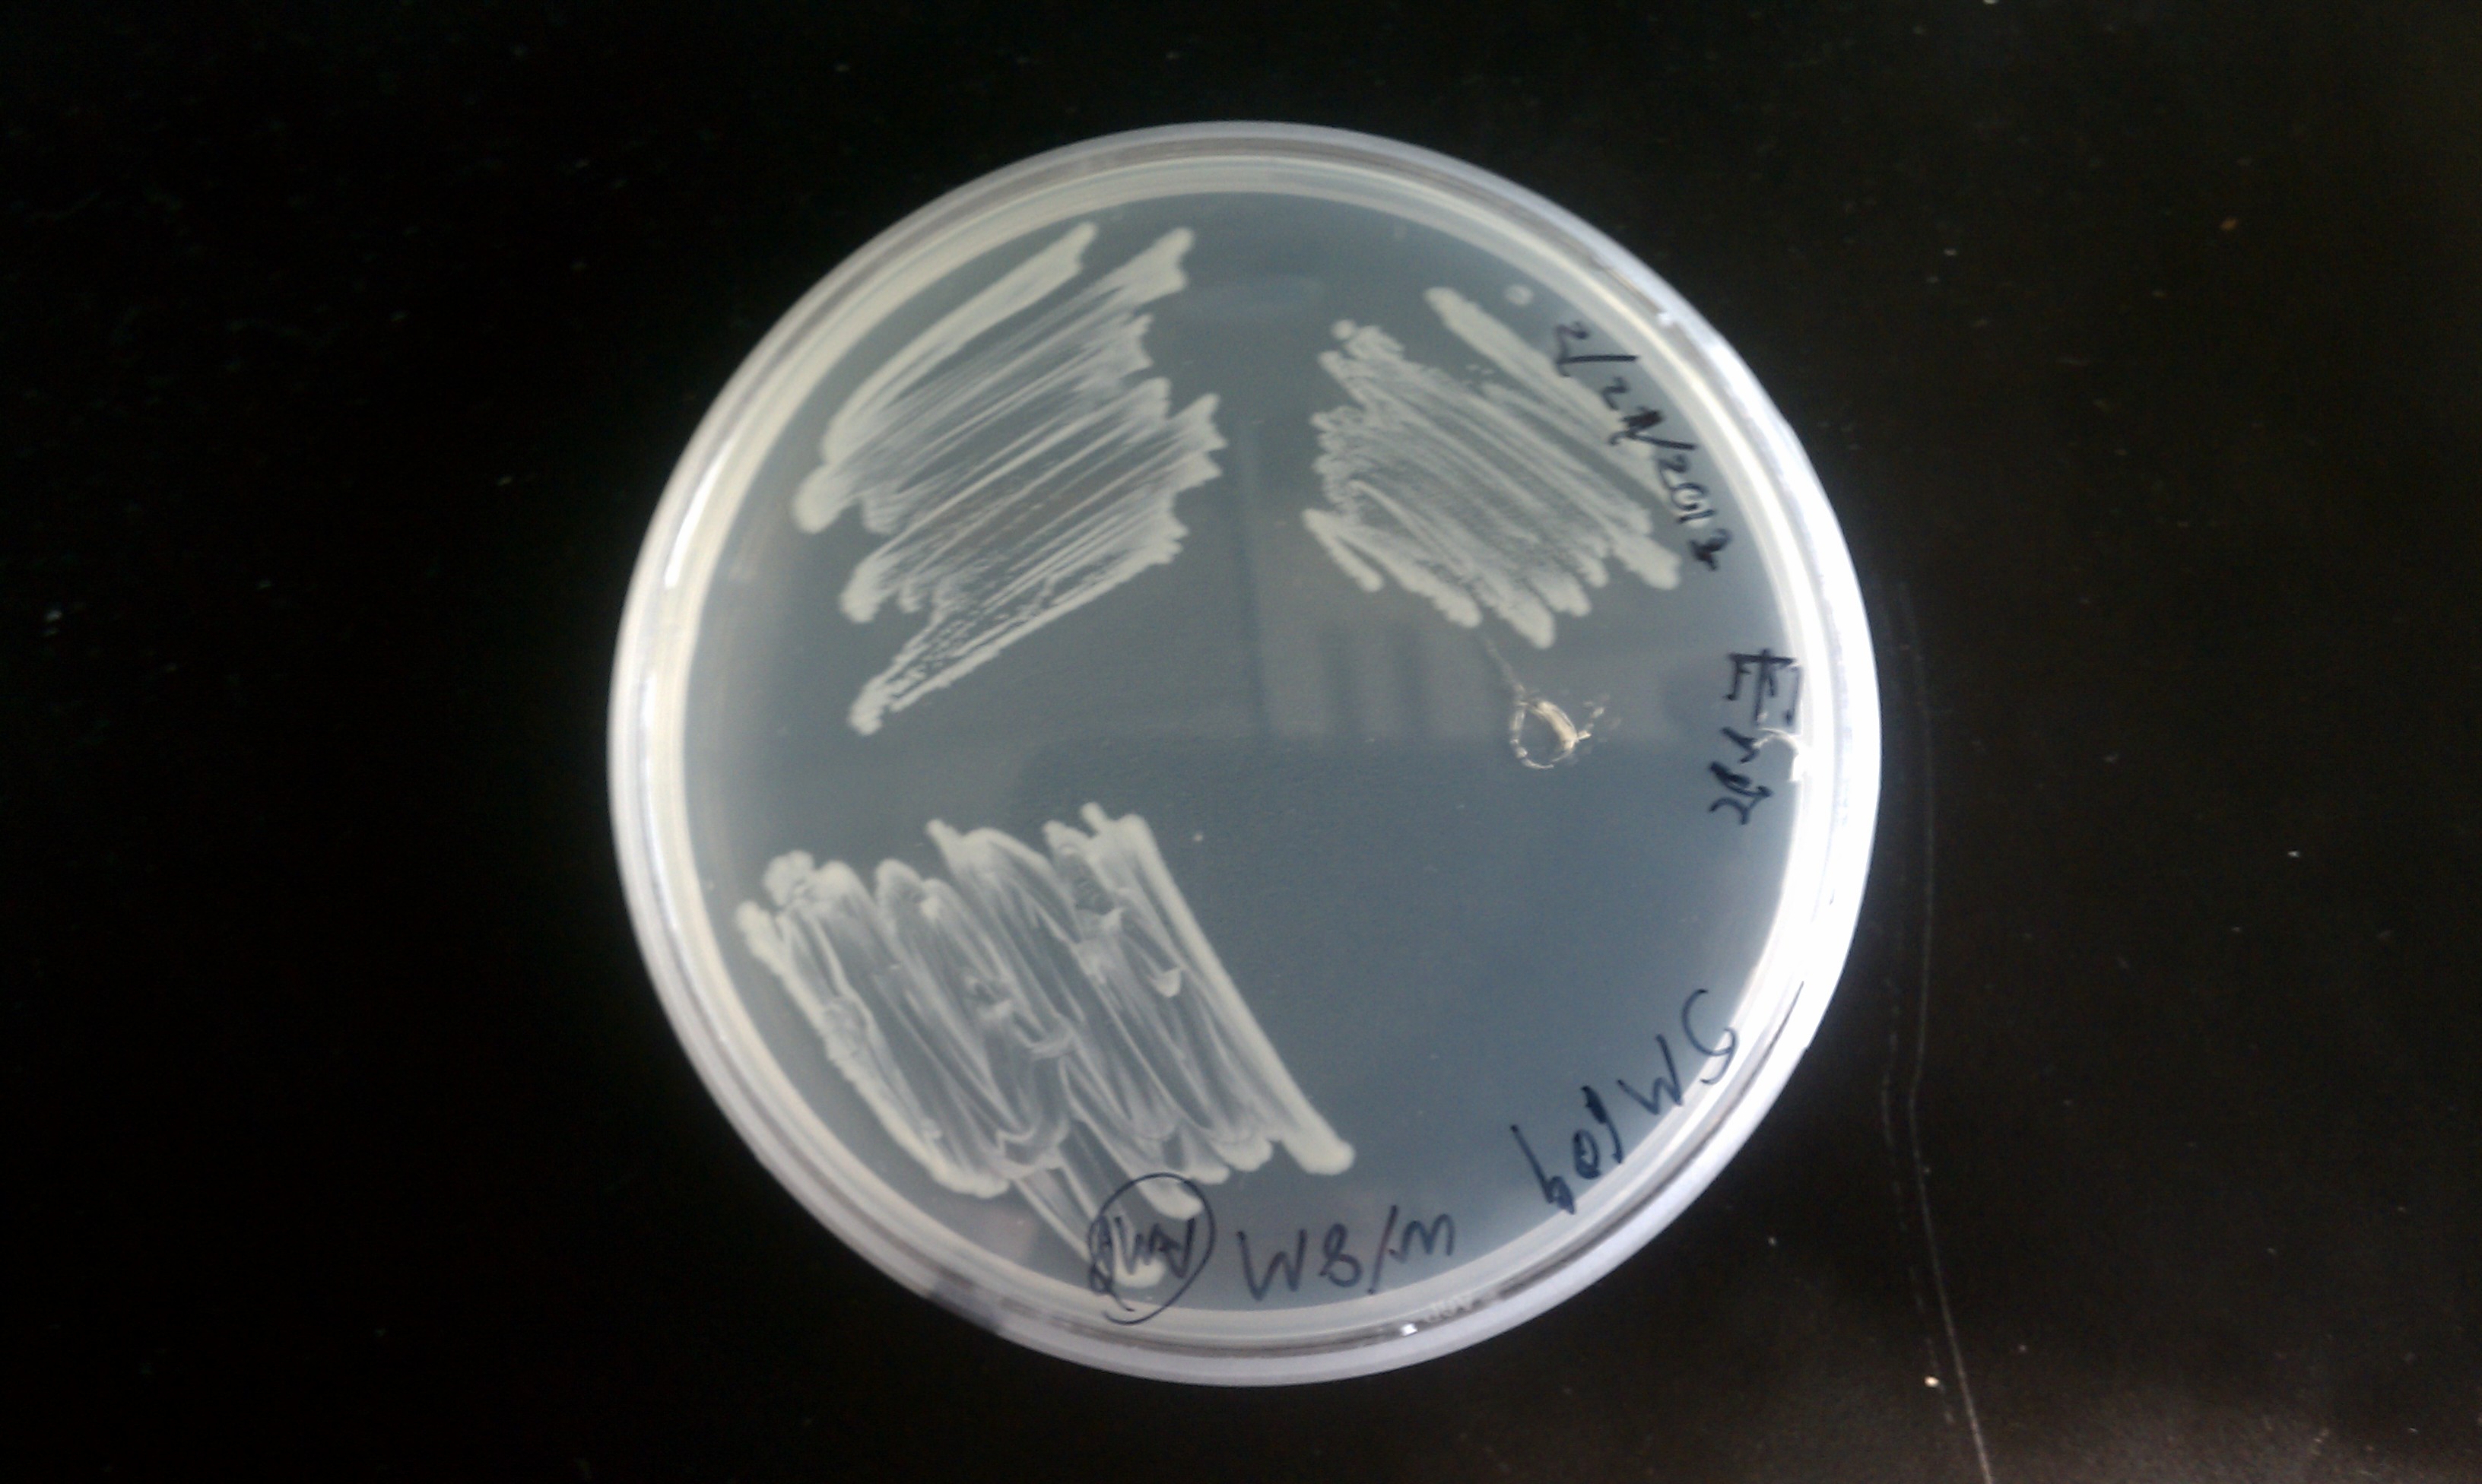
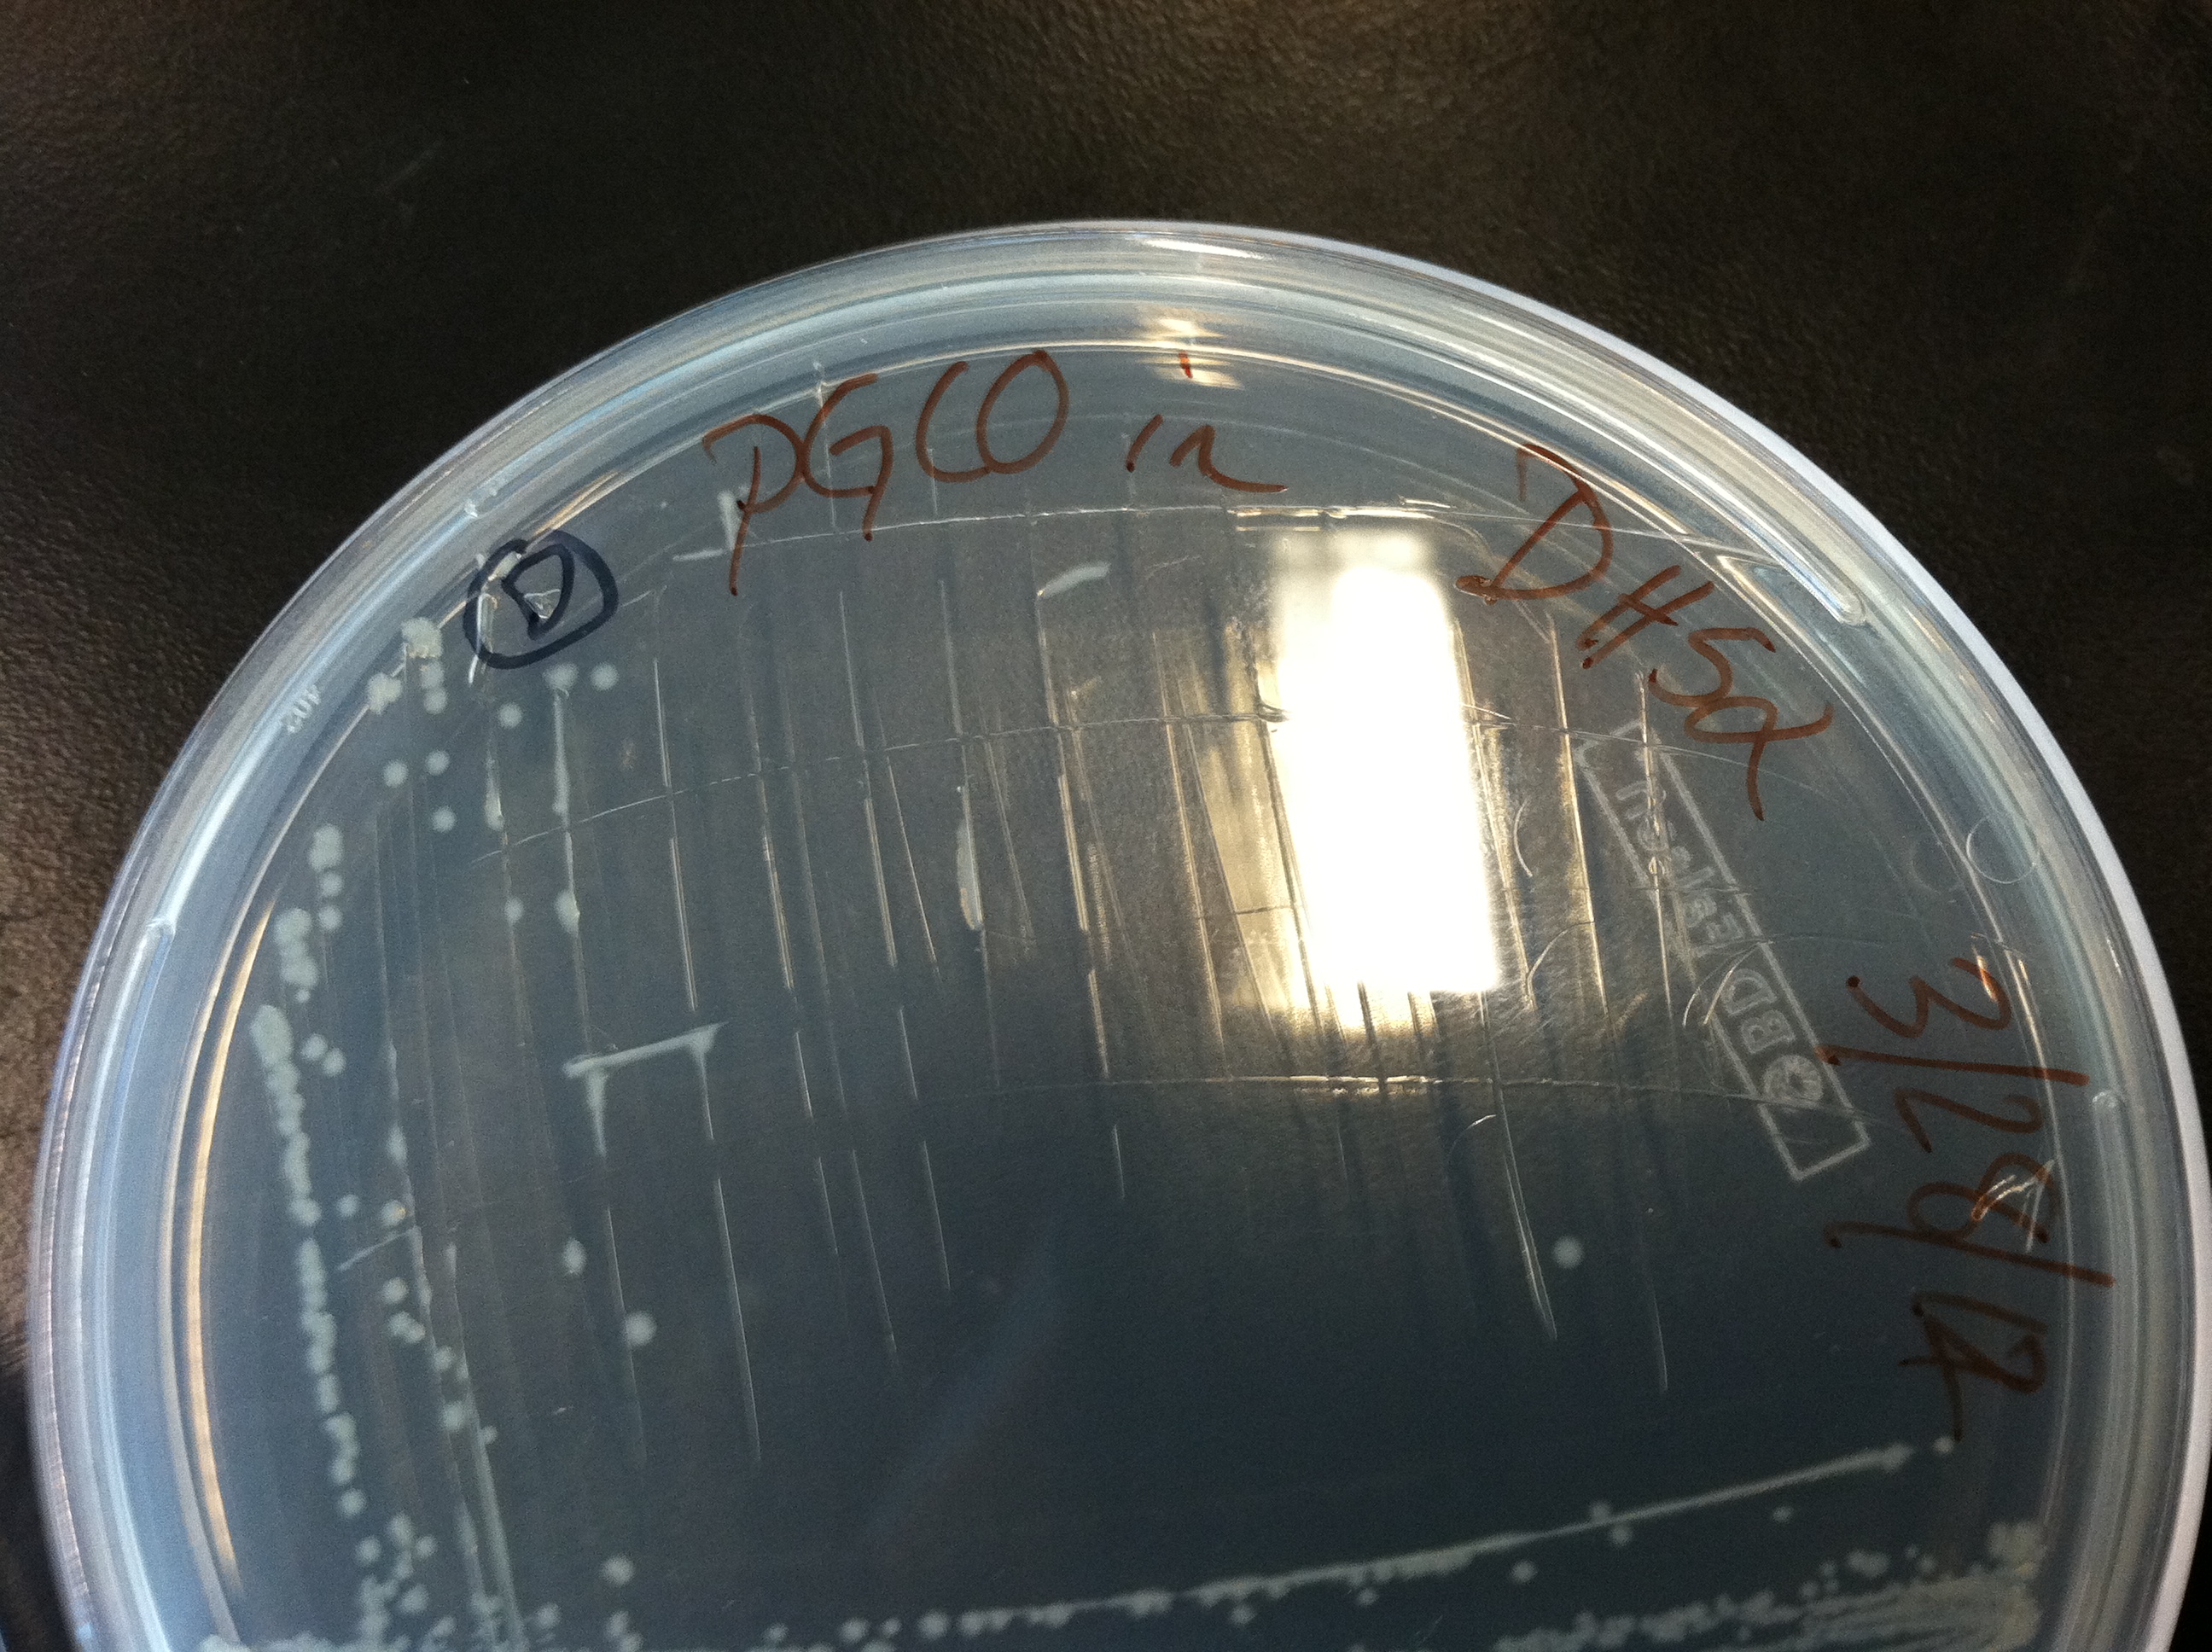
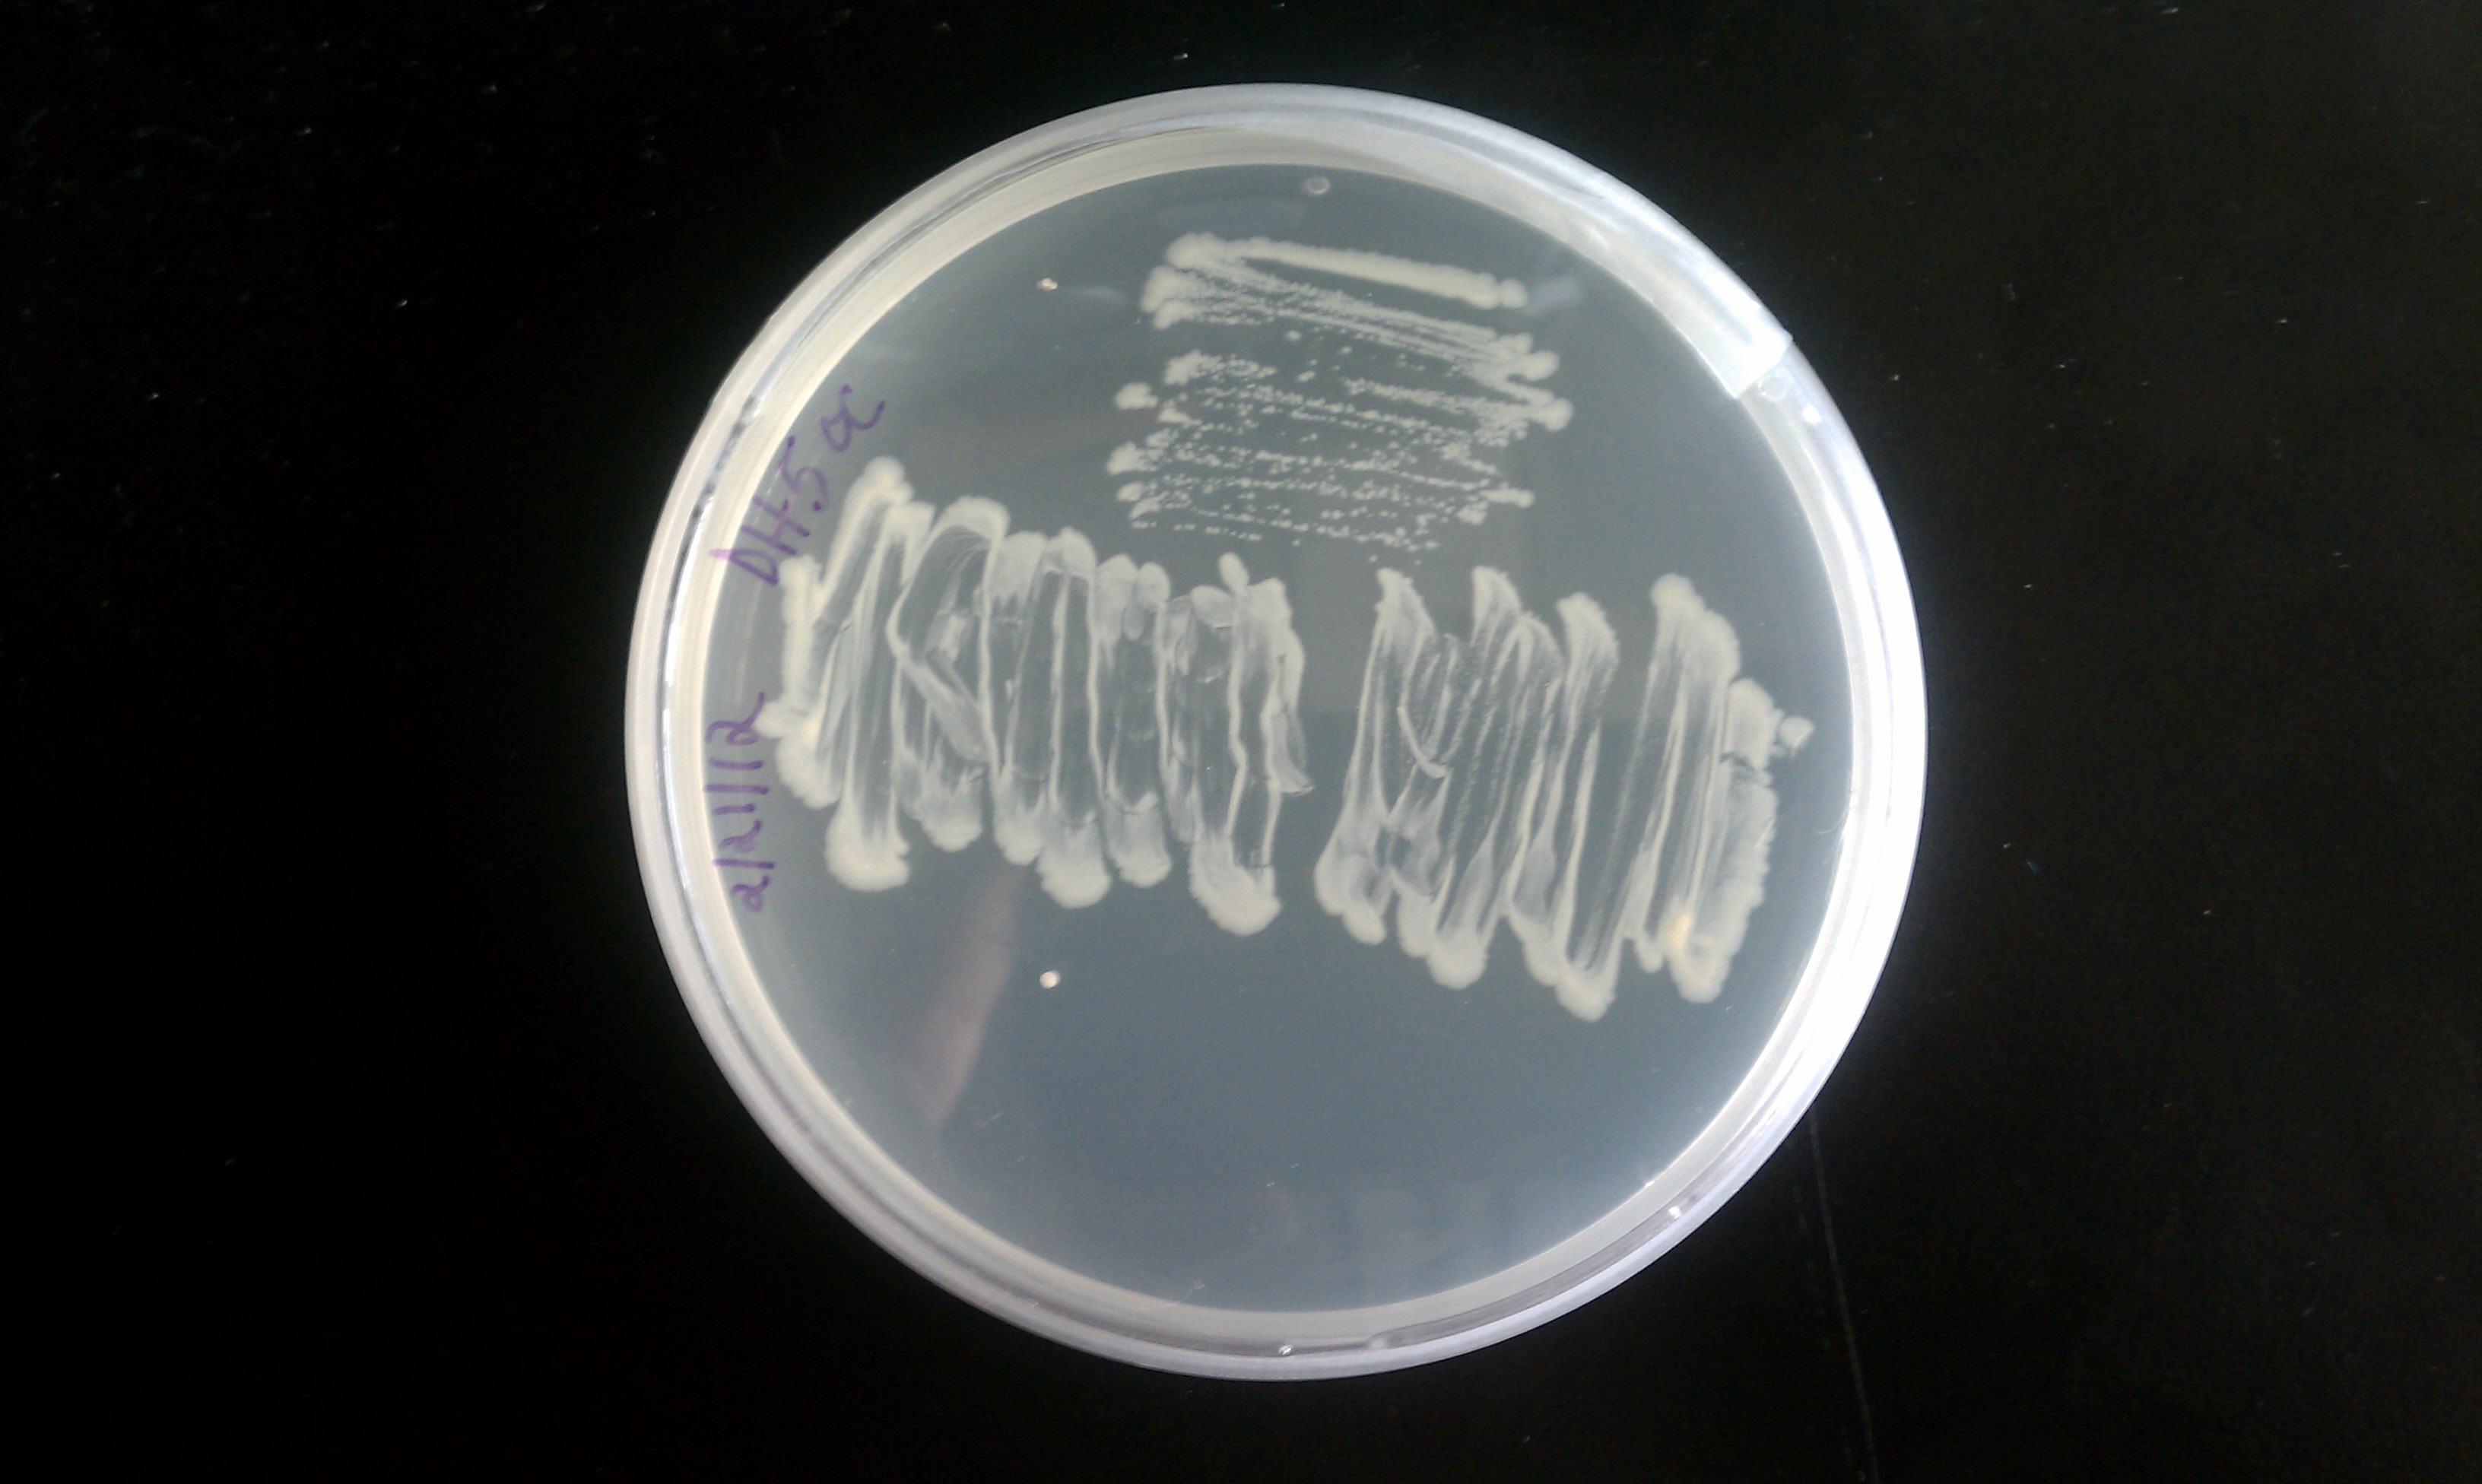
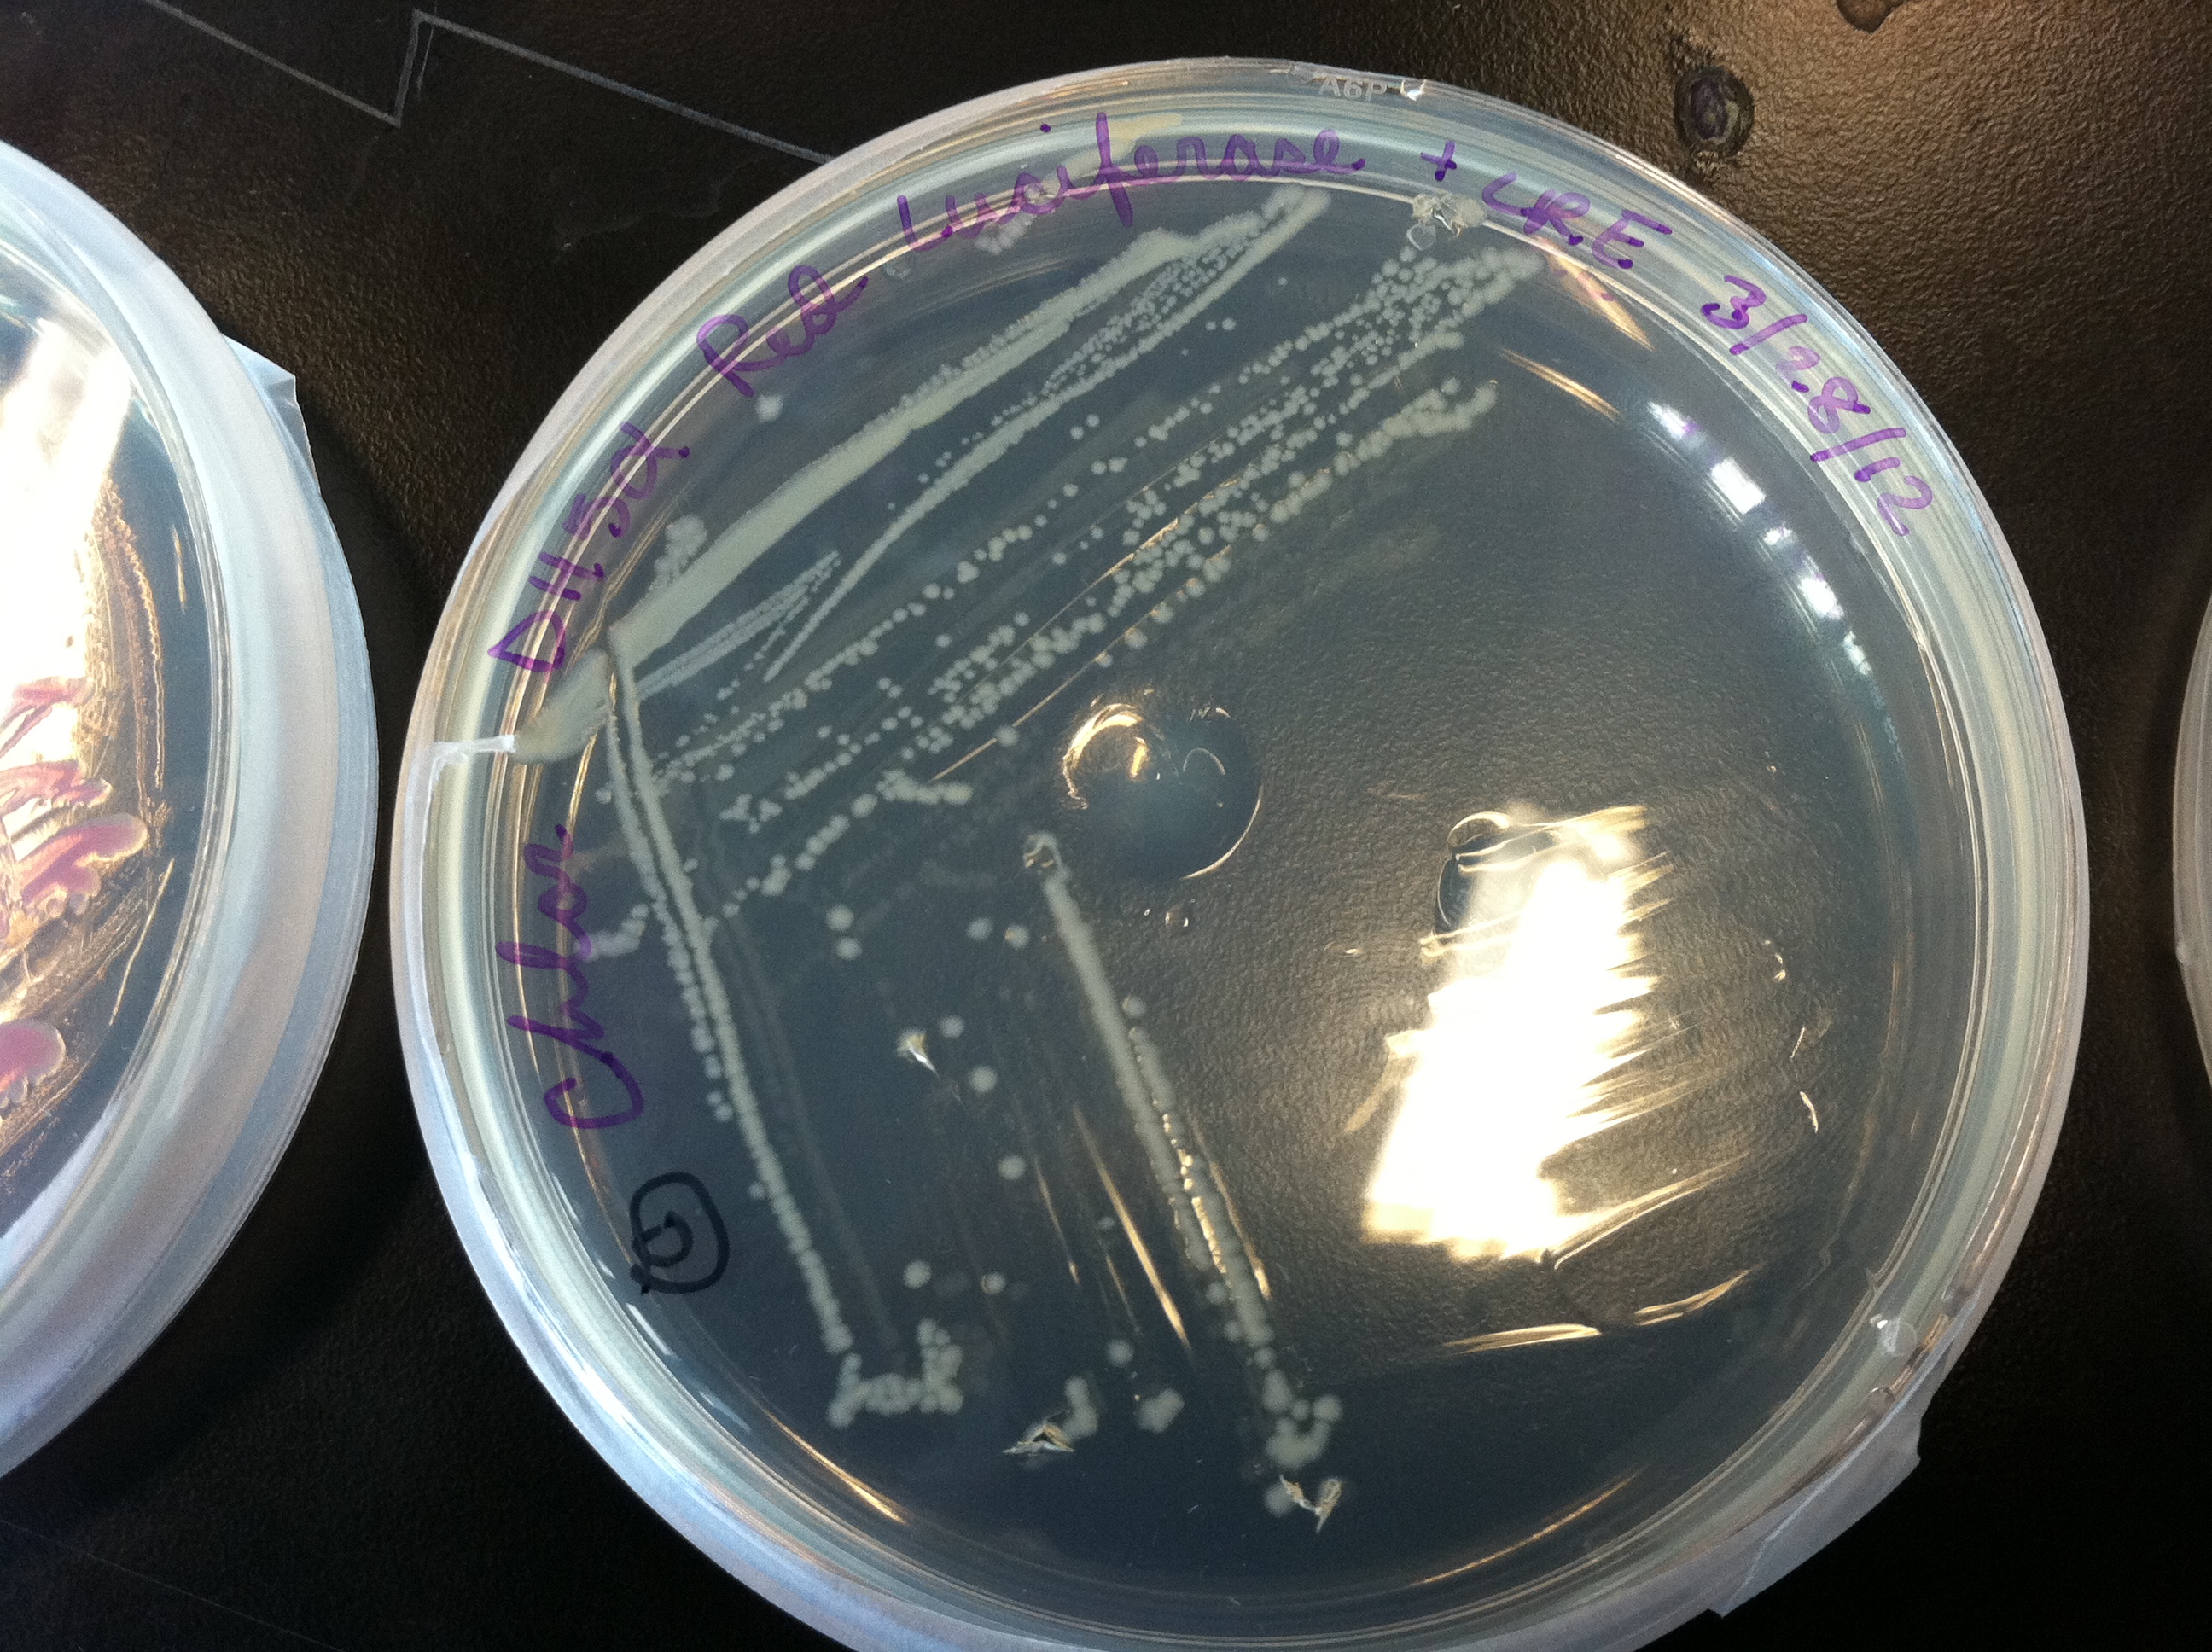
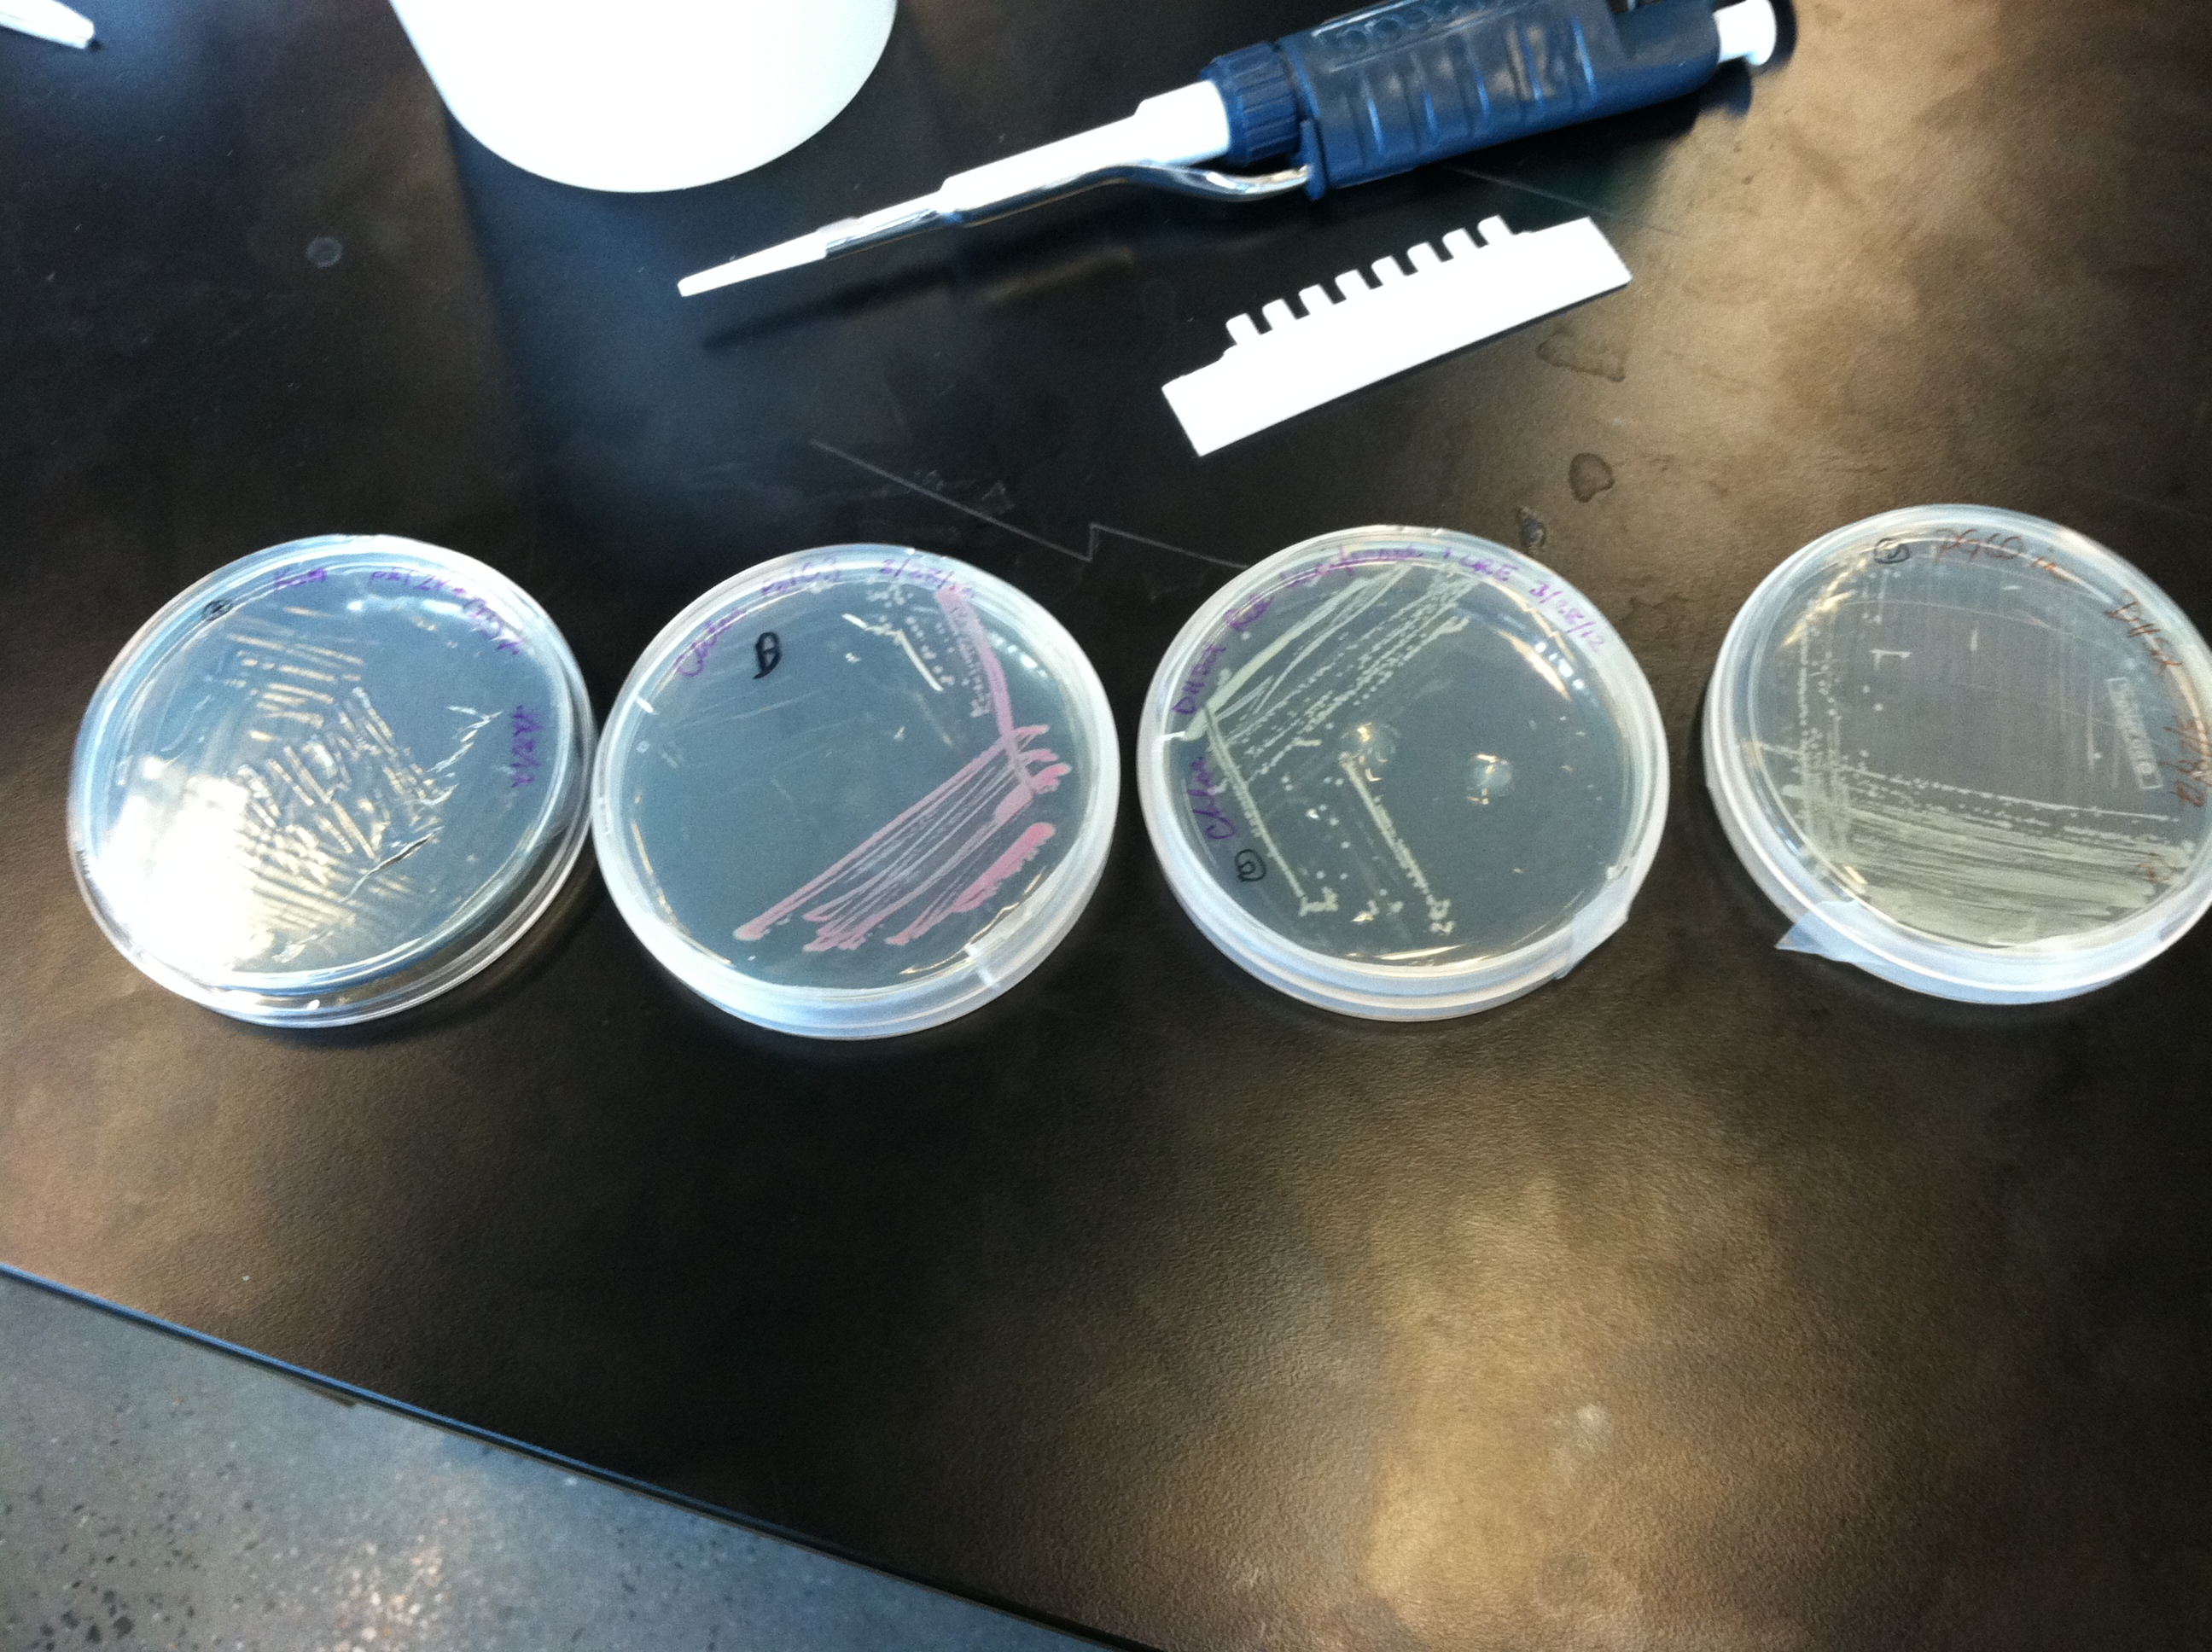
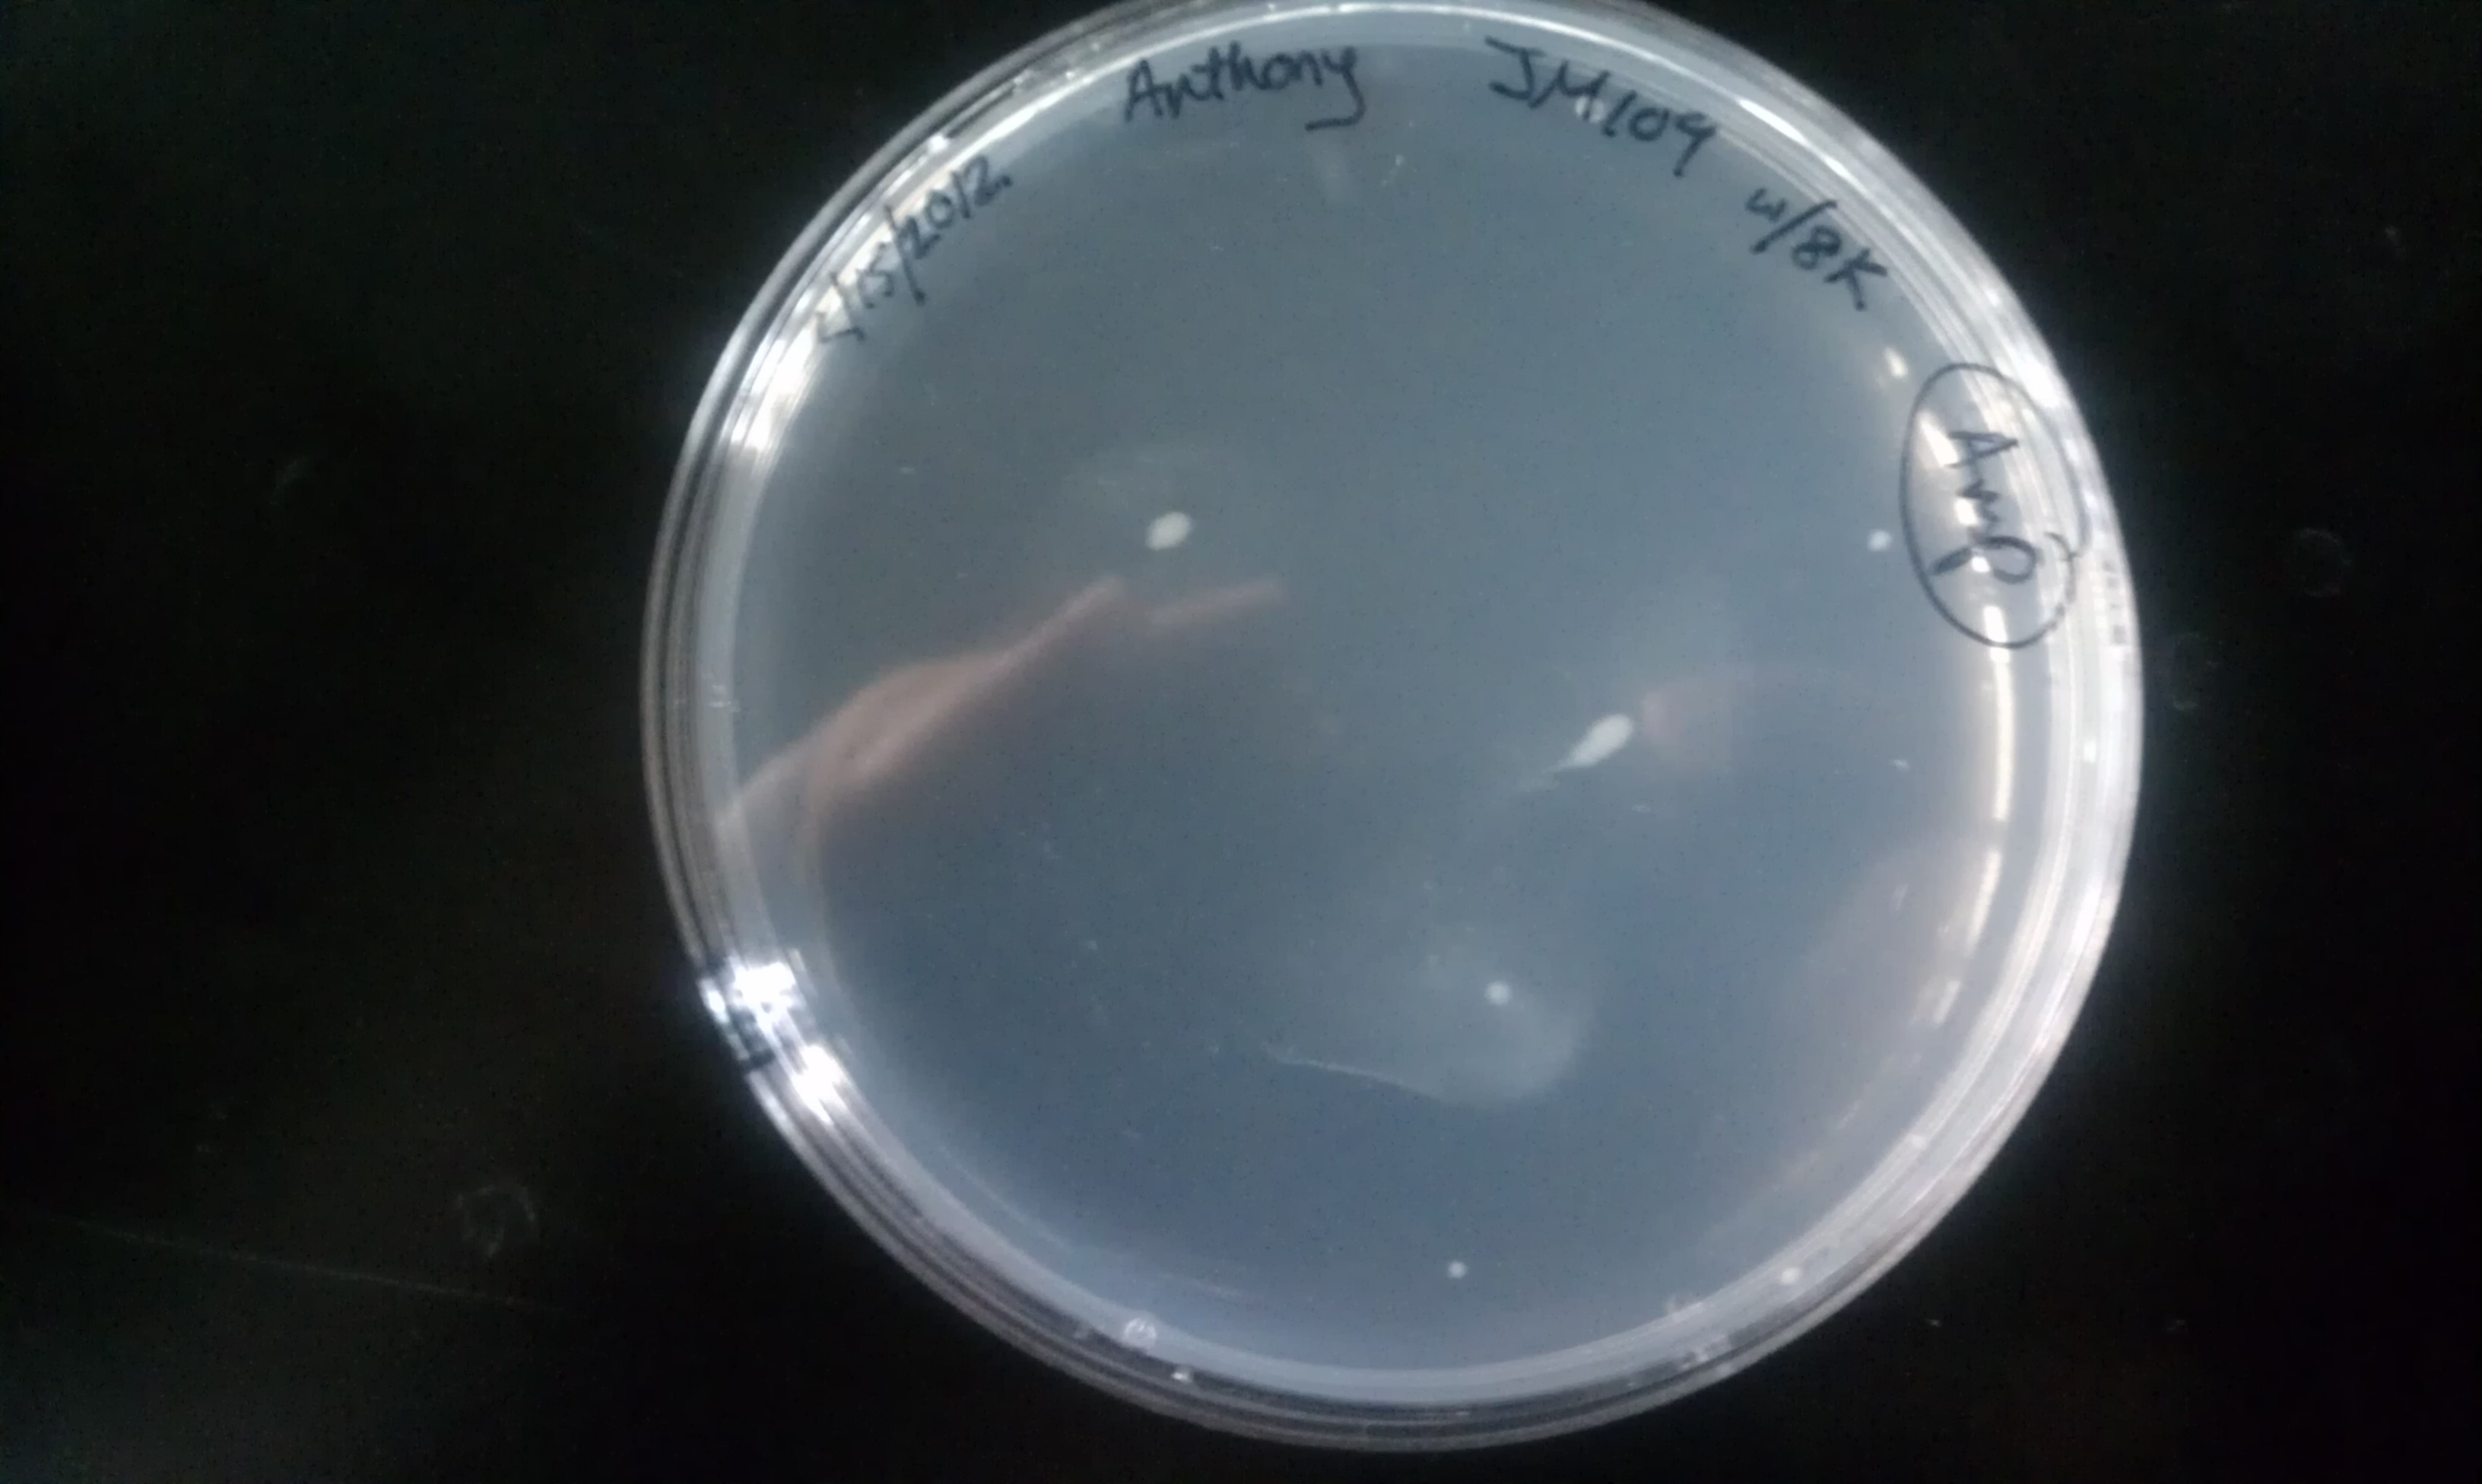
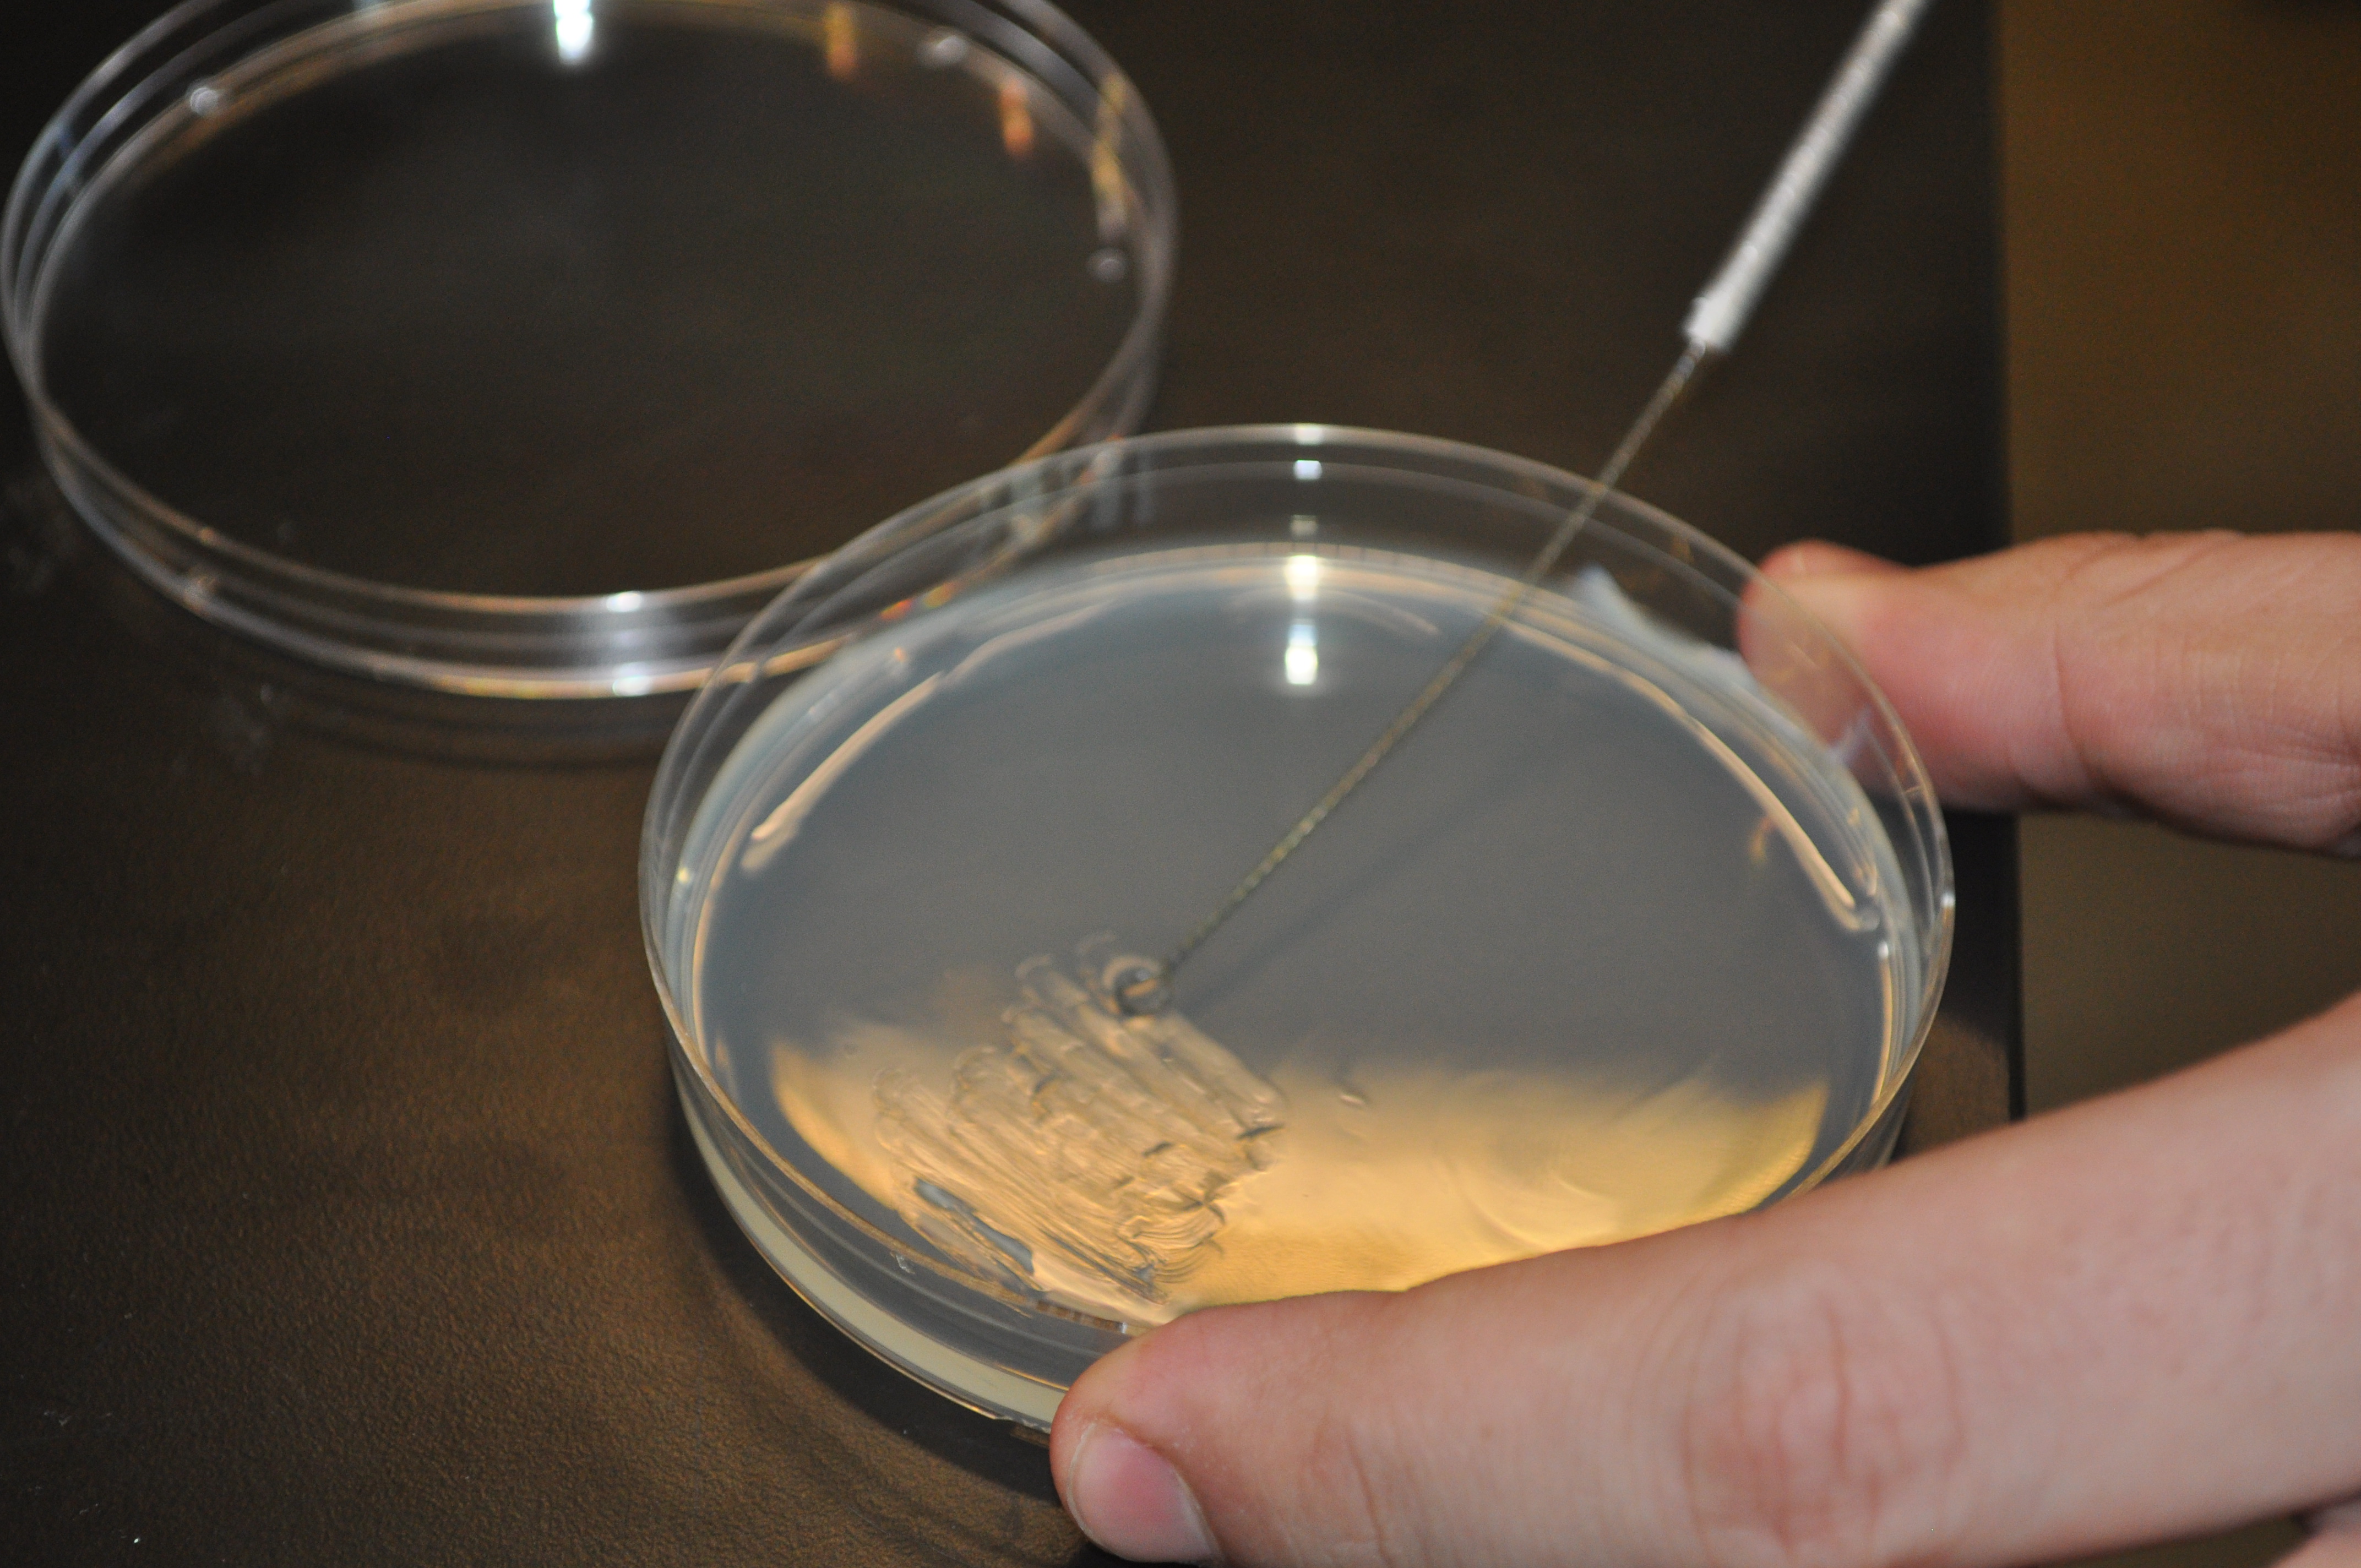
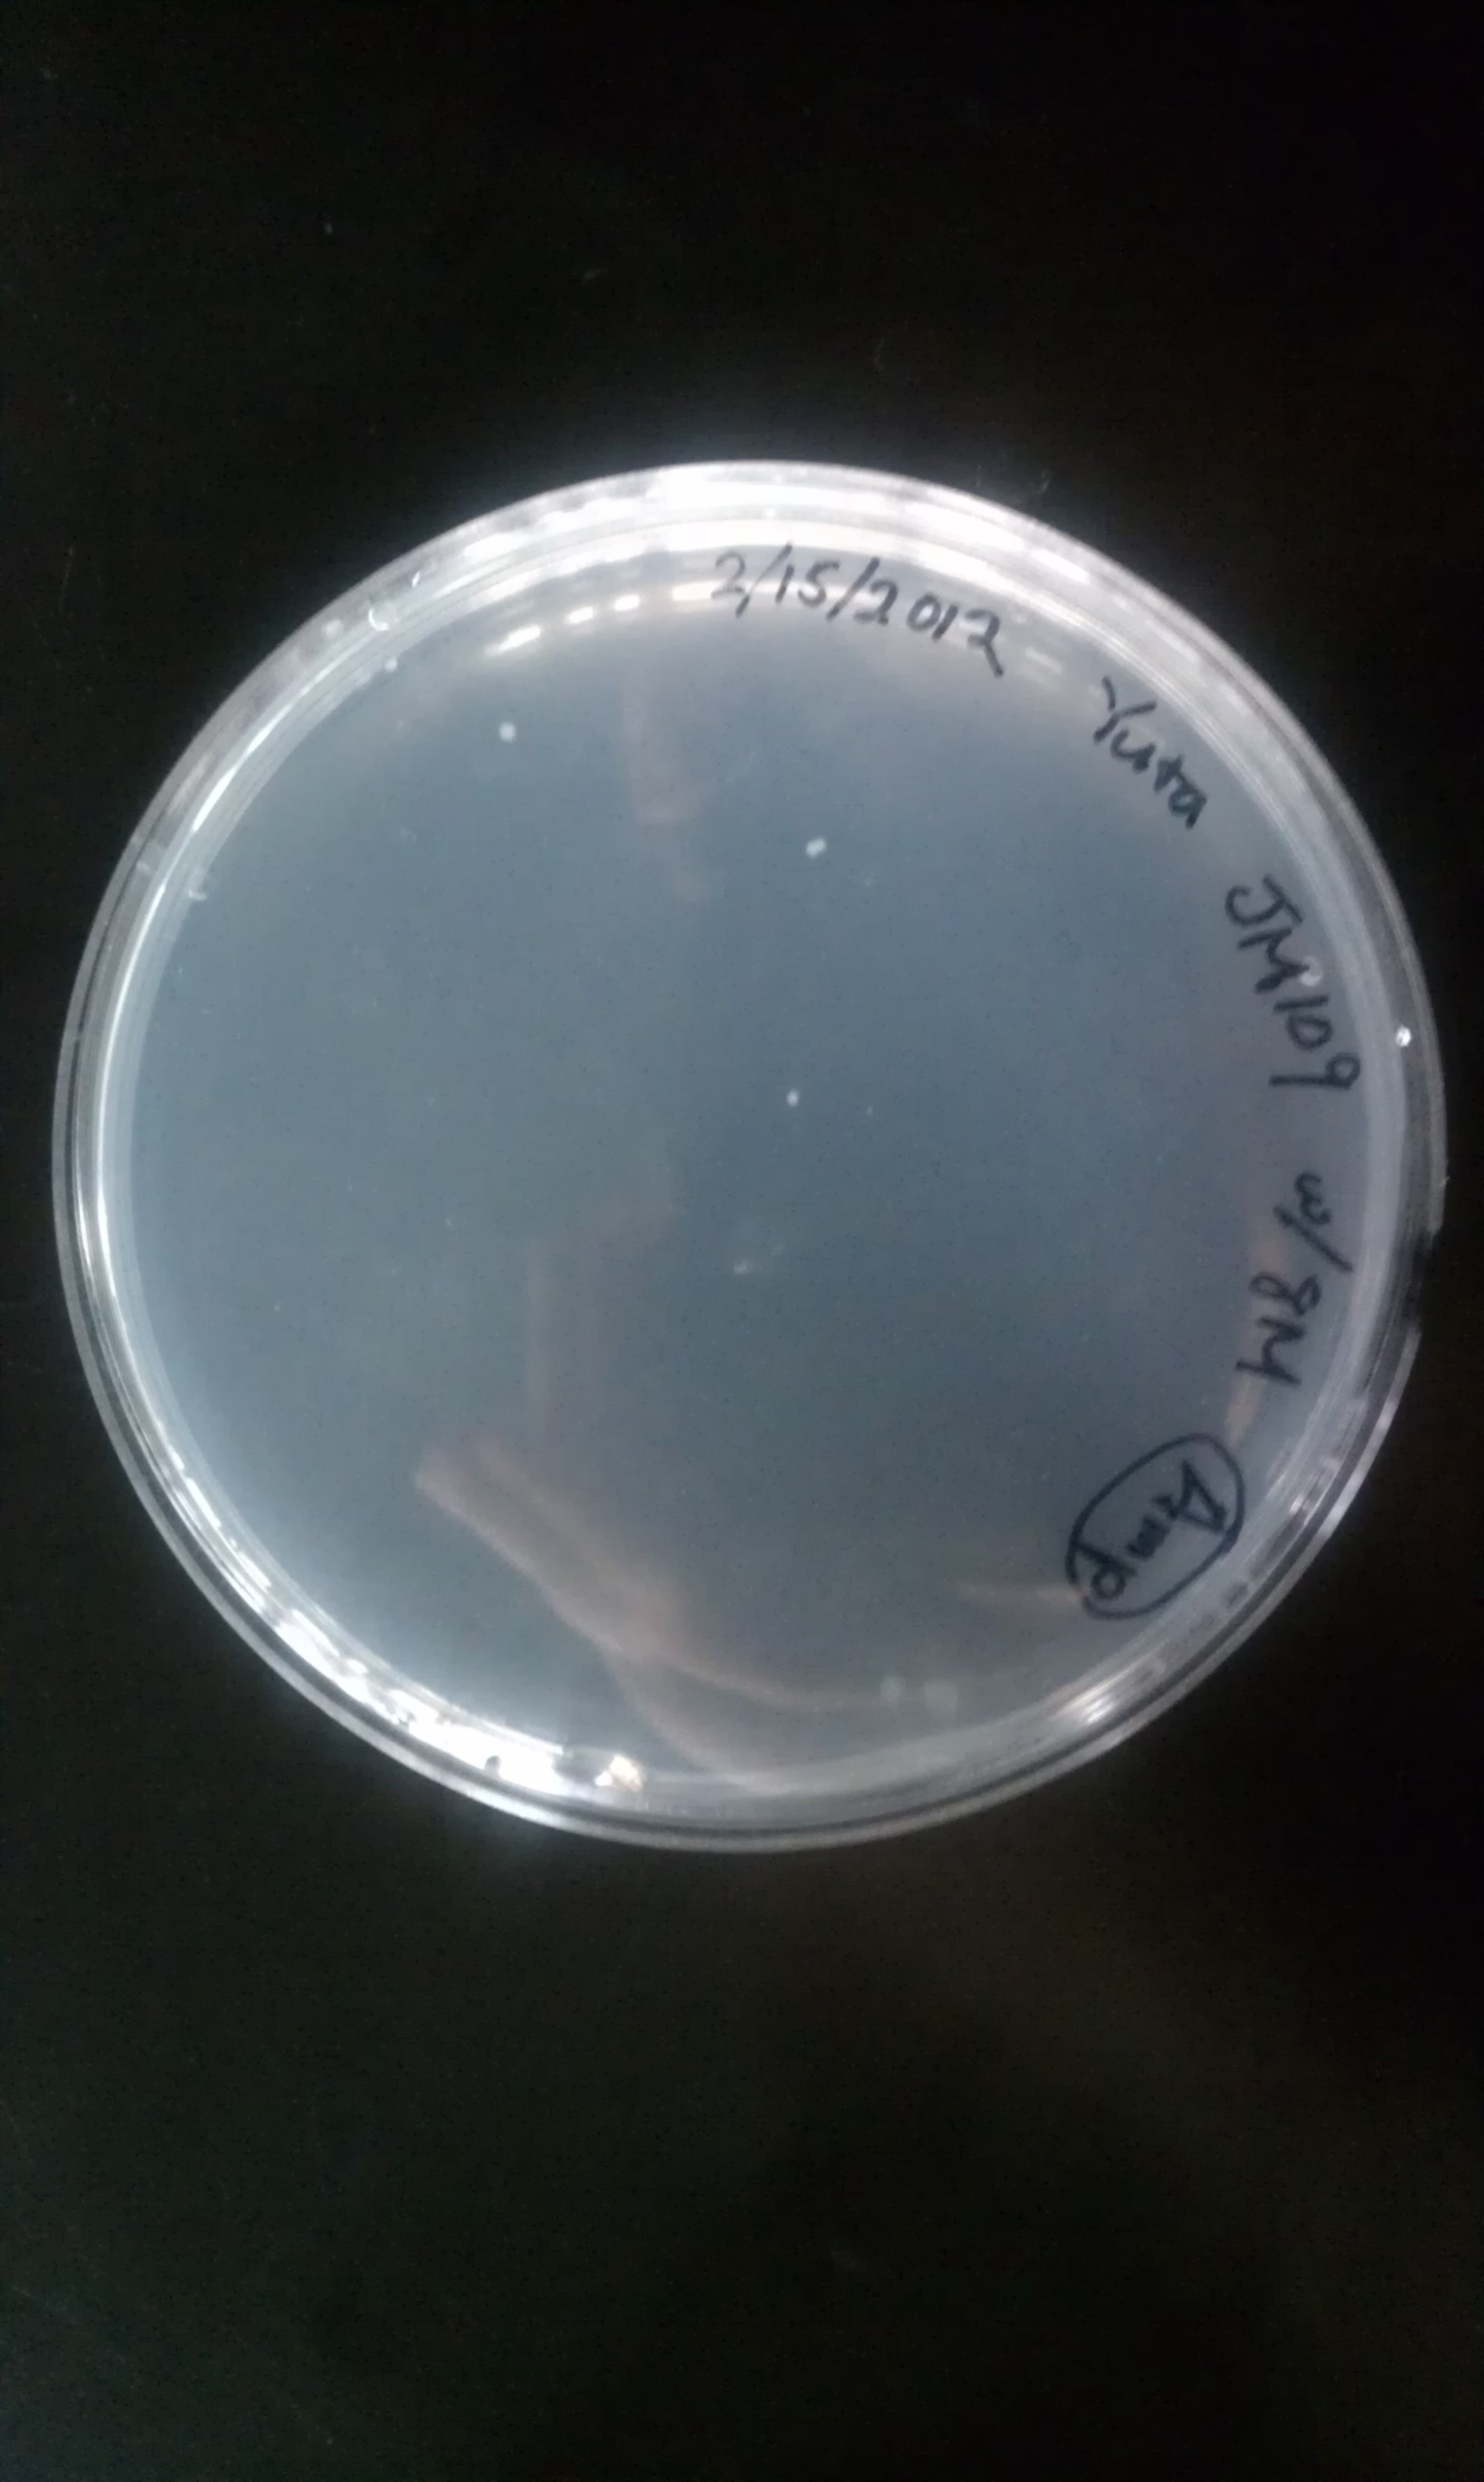
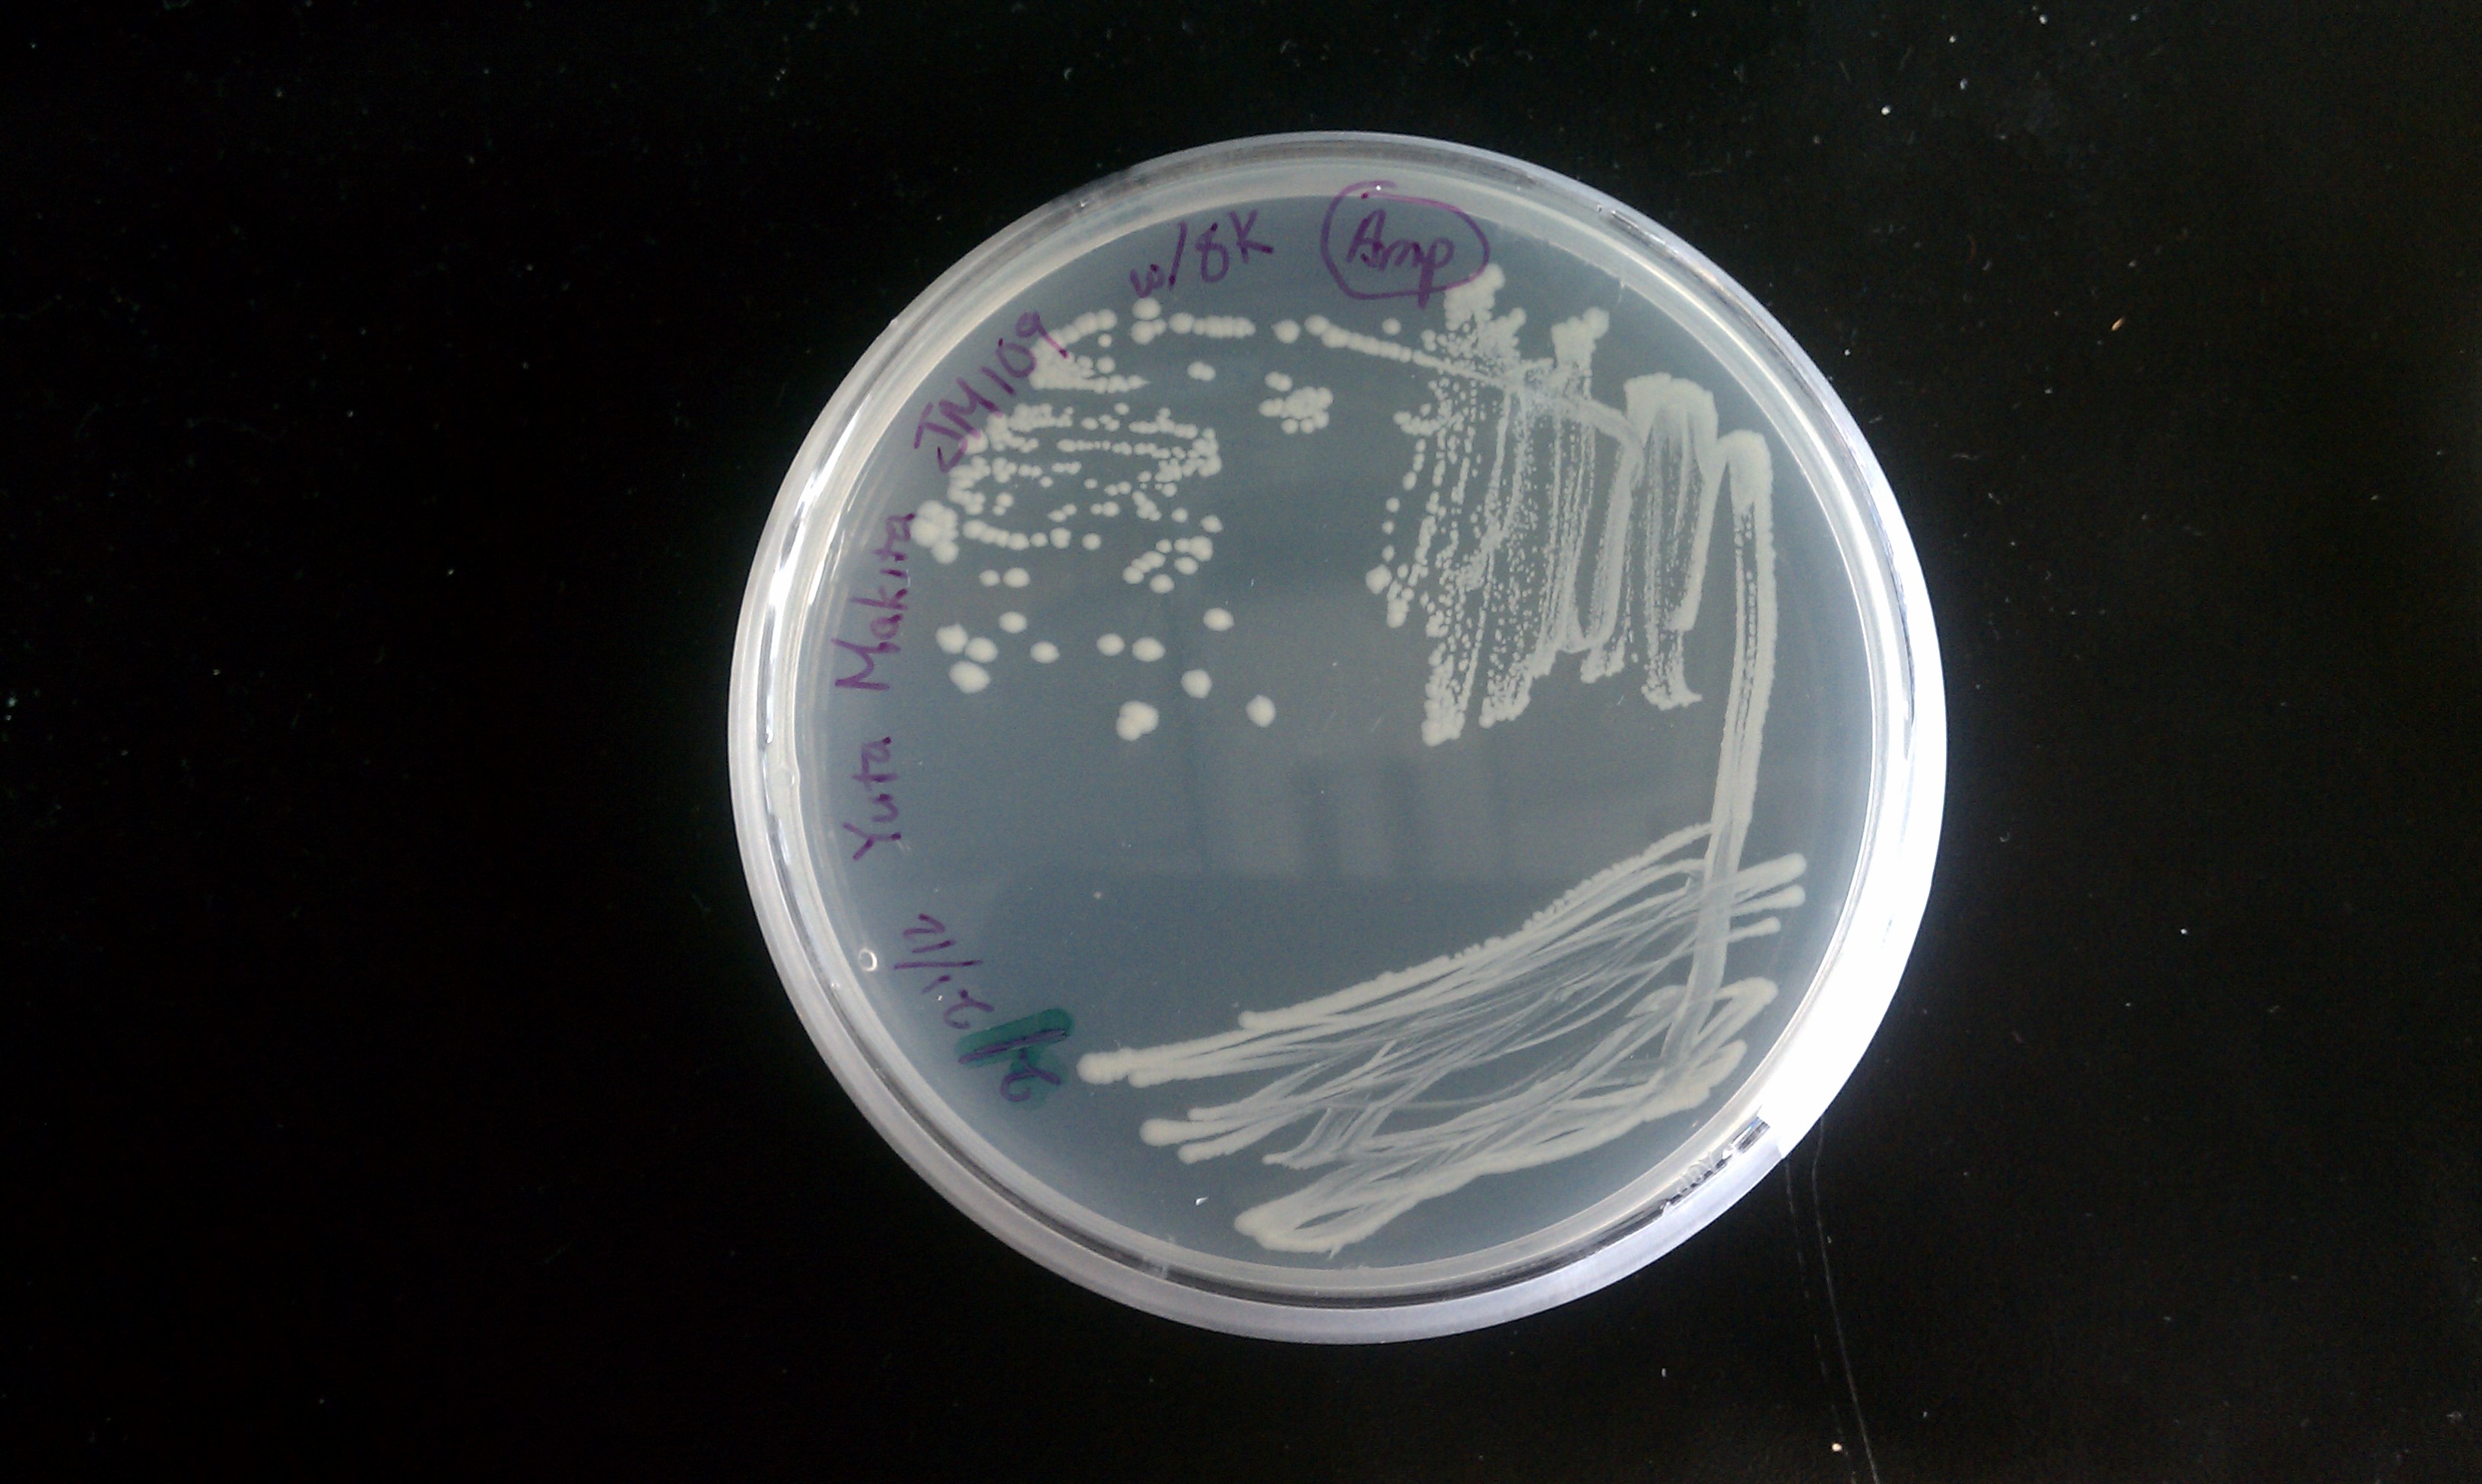
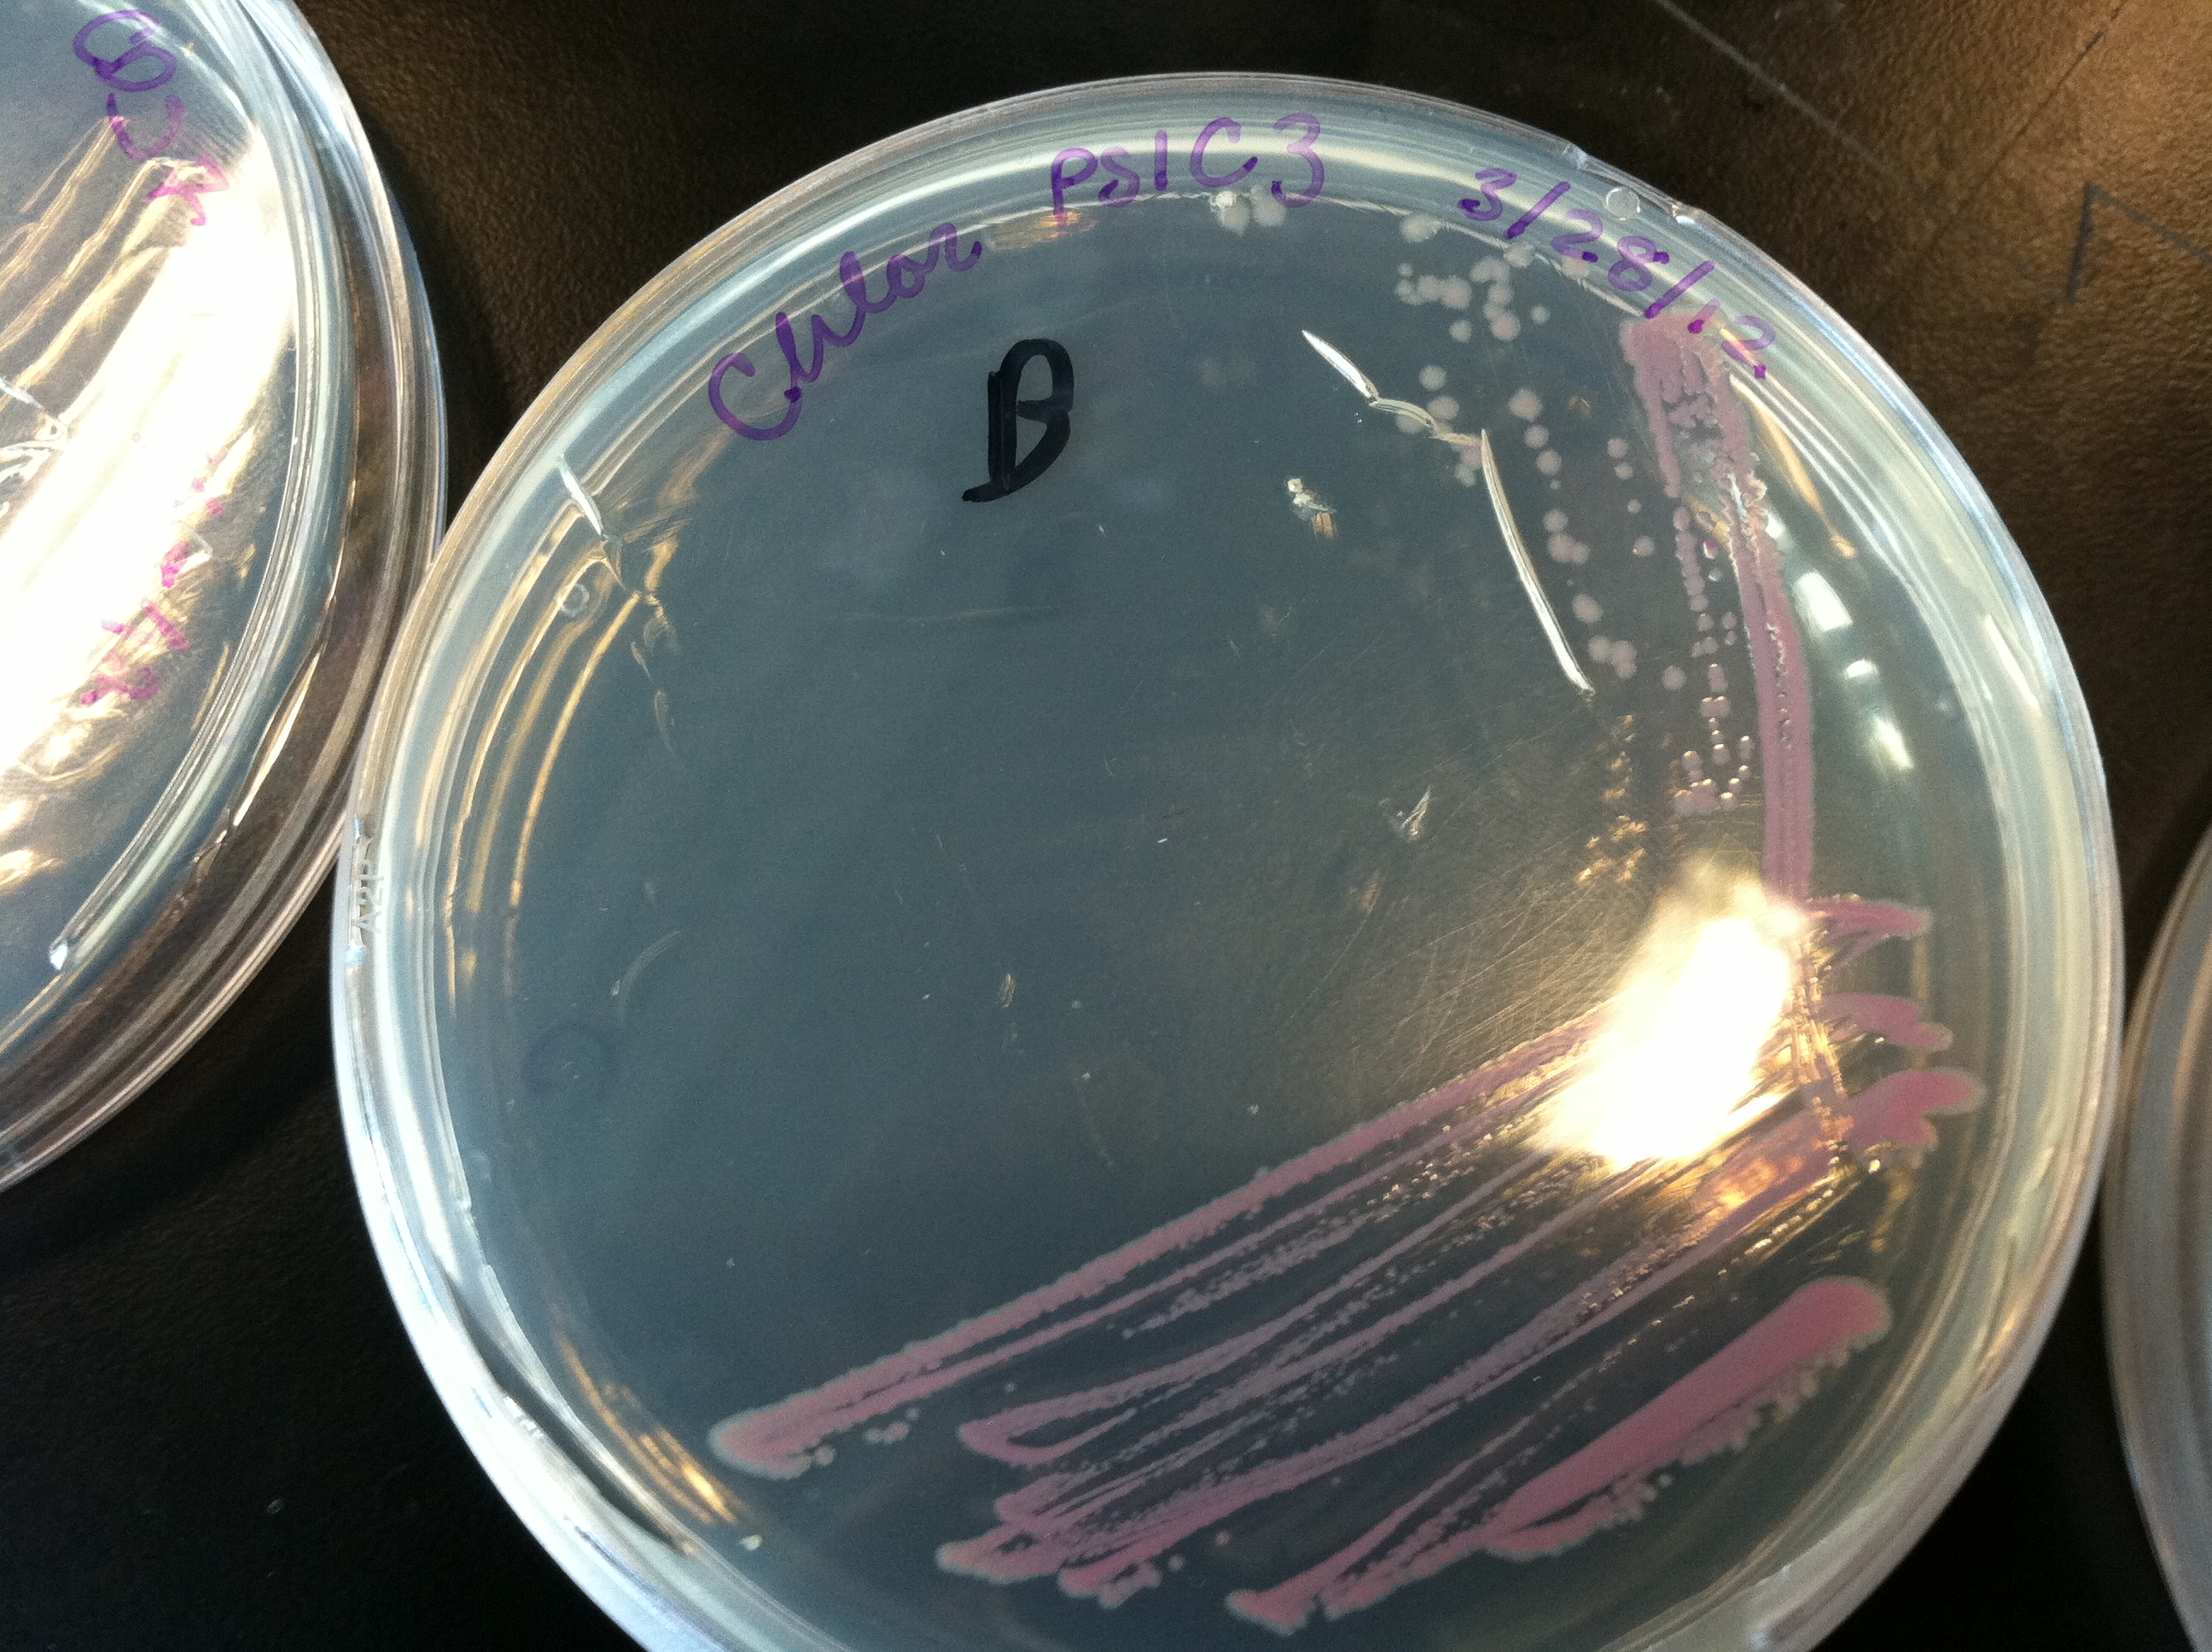
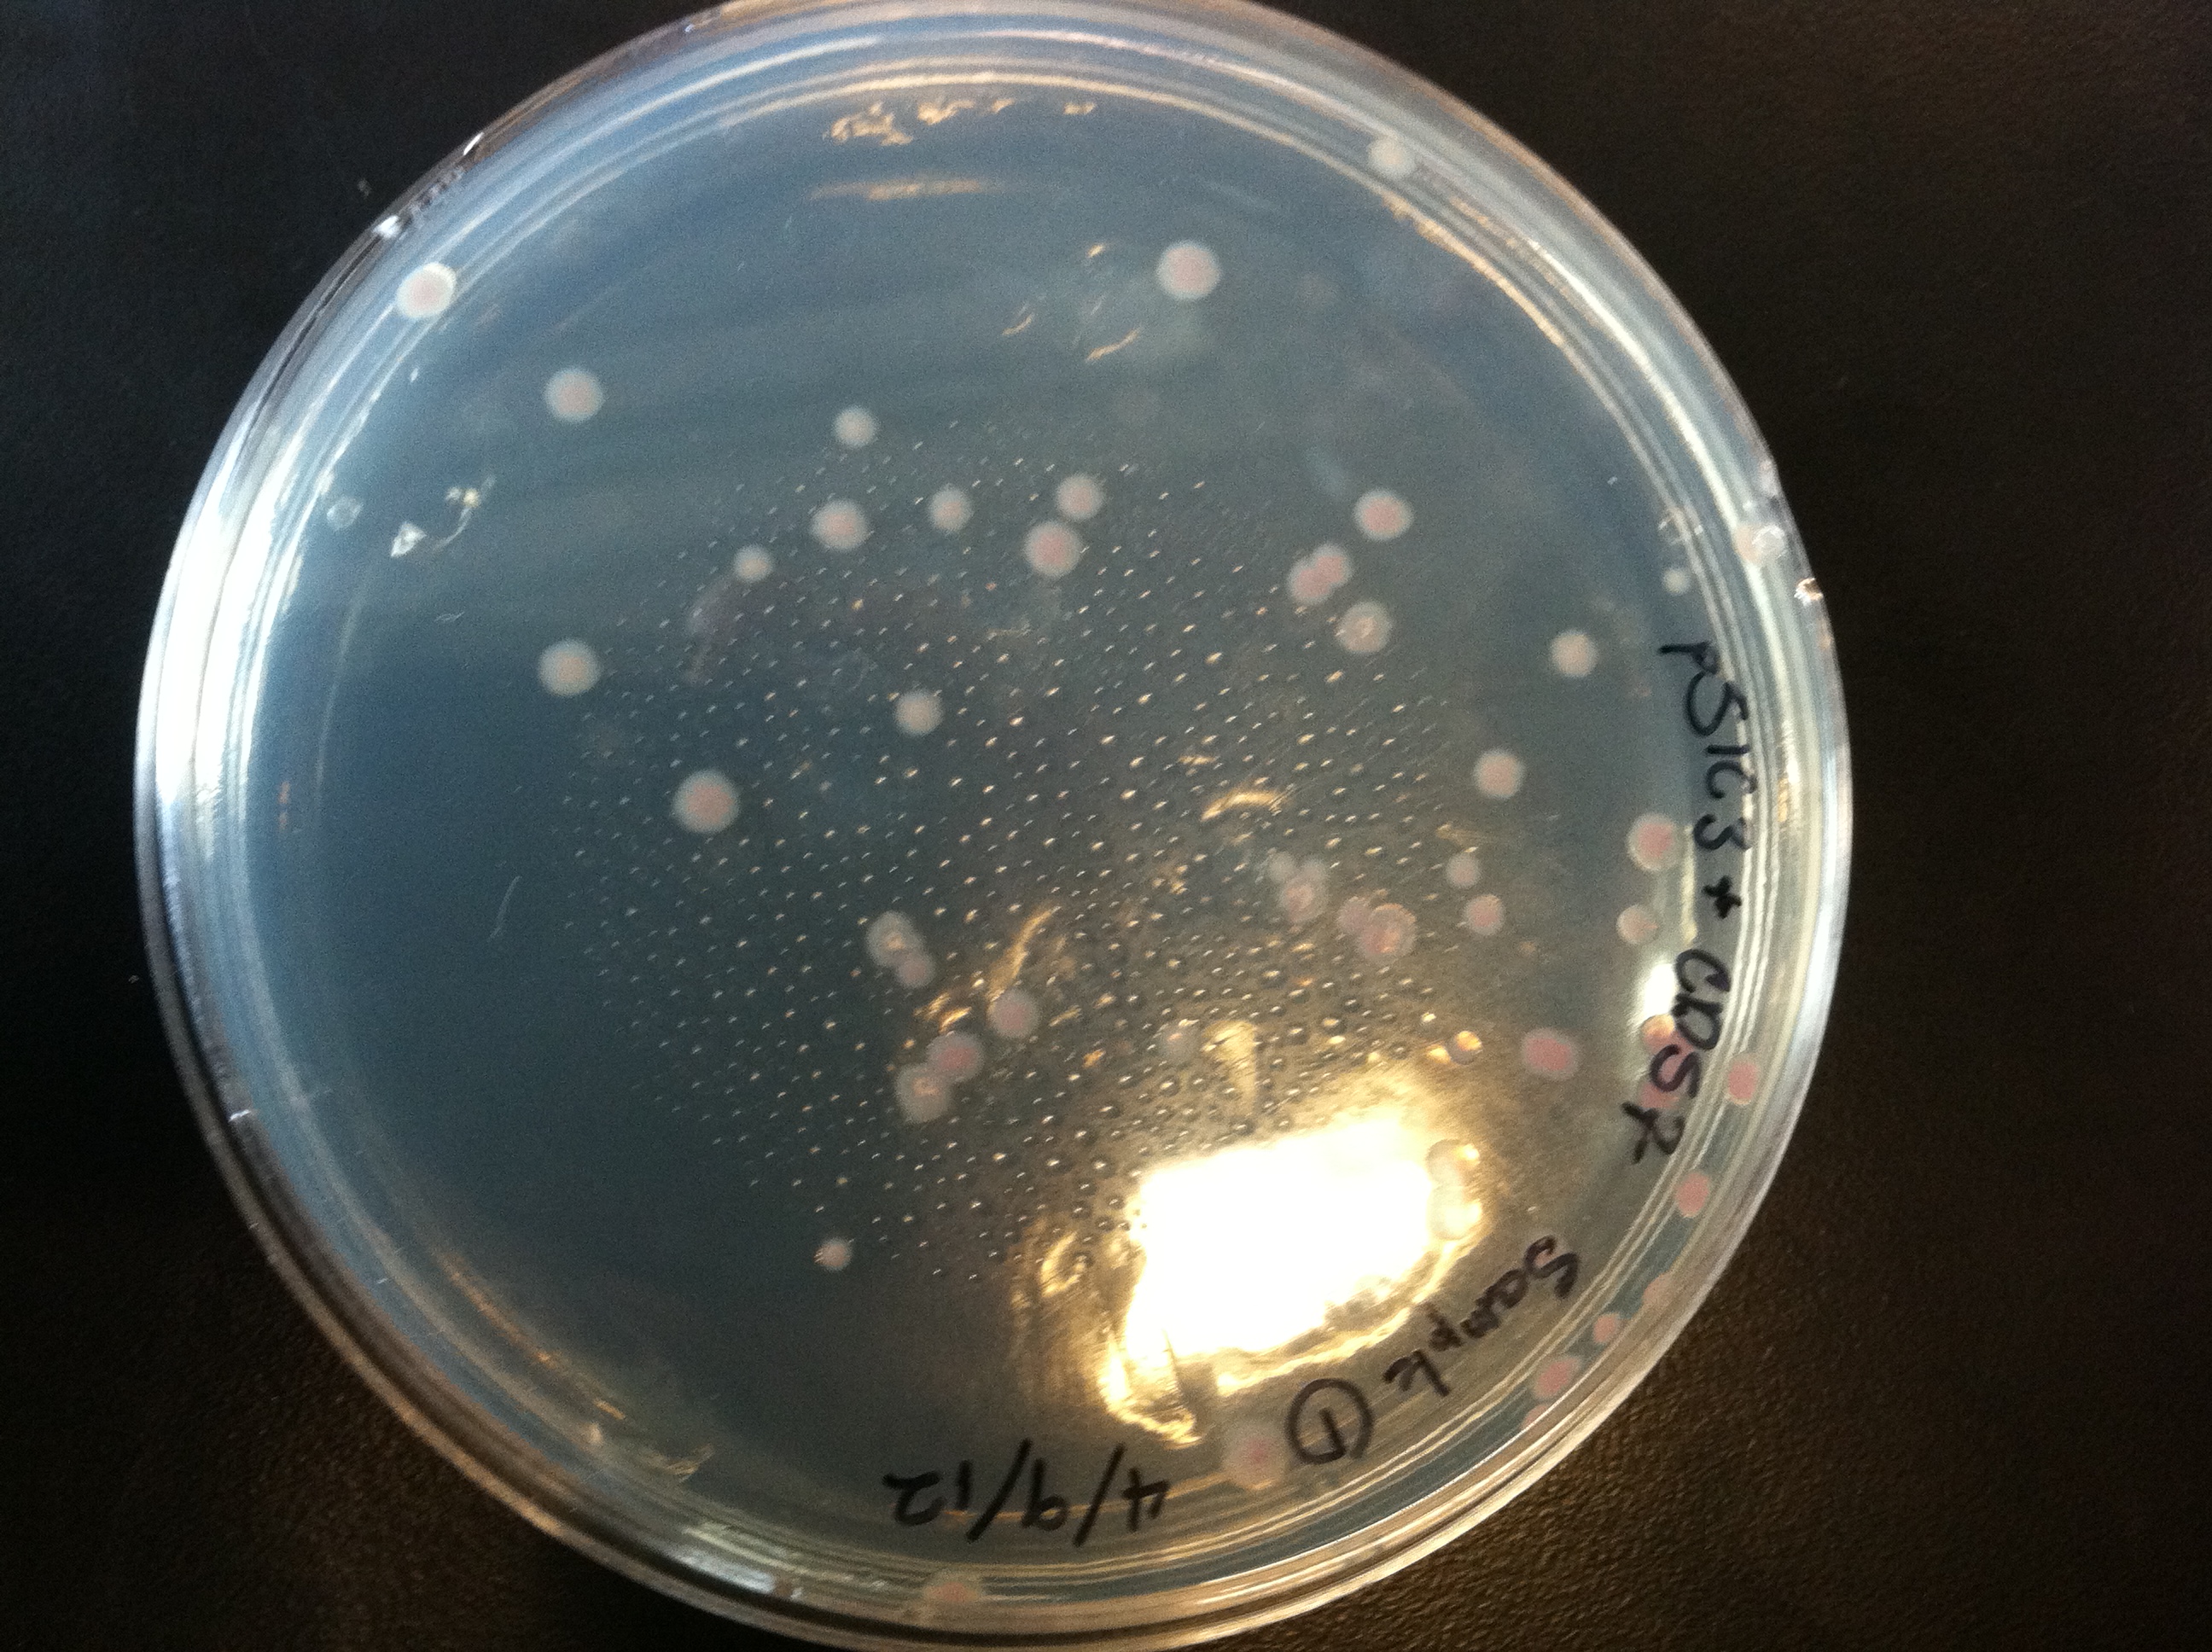

Wednesday, 15th
DNA transformed bacteria growing in petri dish
From left to right, example, Anthony, Stanley, Yuta
Monday, 20th
Samples of commericially used LED lights, photo courtesy Anthony.
Tuesday, 21st (Part 1)
Photos from our lab practical, practicing streaking bacteria and making the agarose gel.
Tuesday, 21st (Part 2)
The end product of the streaking in the lab. From left to right: Anthony, Eric, and Yuta
Back to iGEM